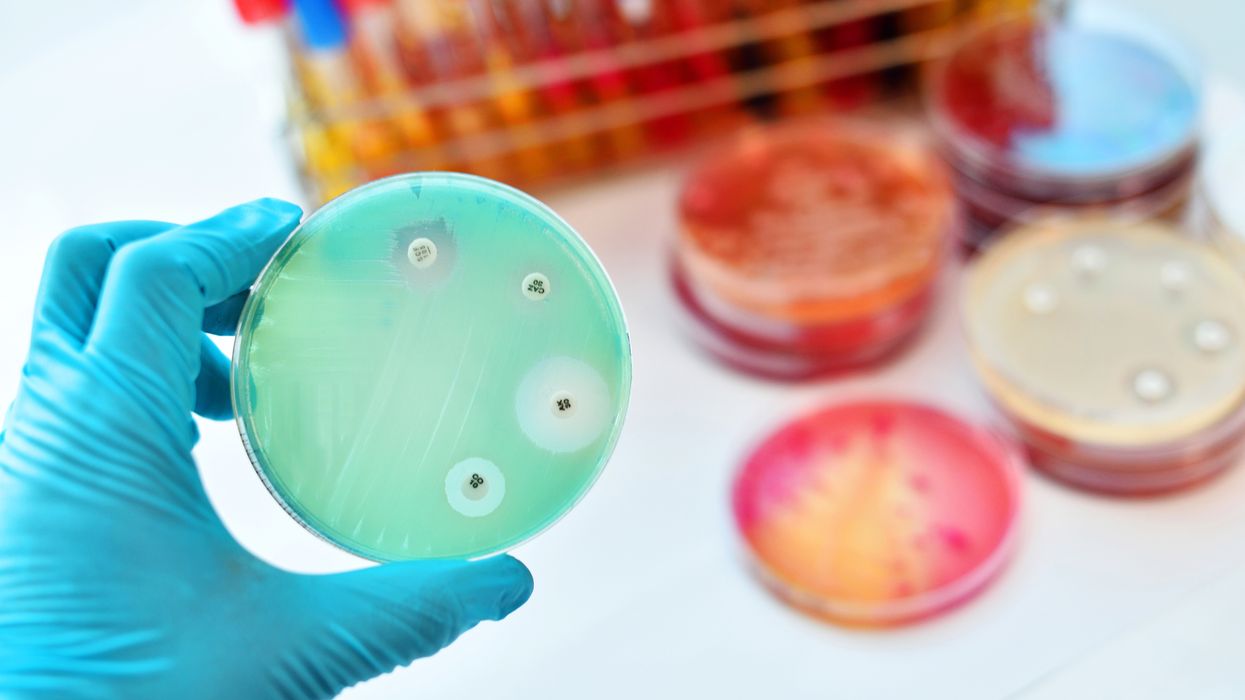
Monkeypox cases are on the rise: Are your workers protected?

Compliance Just Got Easier: Stay ahead of regulatory changes with instant notifications on updates that matter.
['Infectious Diseases', 'Bloodborne Pathogens']
['Bloodborne Pathogens', 'Infectious Diseases']
2022-08-15T05:00:00Z
JOIN TODAY TO CONTINUE READING THIS ARTICLE & OTHER INDUSTRY NEWS!
You'll also get exclusive access to:
A database of easy-to-understand regulationsAsk unlimited questions to our expertsPre-led discussions forumsAnd more
TRY IT FREE TODAY
Already have an account? Log in now.
NewsIndustry NewsInfectious DiseasesBloodborne PathogensInfectious DiseasesIn-Depth ArticleBloodborne PathogensEnglishFocus AreaUSA
Monkeypox cases are on the rise: Are your workers protected?
2022-08-15T05:00:00Z
Monkeypox is on the rise, demanding employers take action to protect their workers from exposure. Employers must ensure a workplace free of recognized hazards, including pathogens like monkeypox. Protecting workers requires developing, implementing, and communicating a plan with specific procedures that includes worker interactions, personal hygiene, and sanitation of facilities.
As of August 10, 2022, the Center for Disease Control (CDC) reported a rise of monkeypox to 10,392 total confirmed cases in the United States, an increase from only one in May of 2022. As the CDC monitors and responds to this rapidly spreading threat, employers should also. Proactive monitoring and response ensure employers are complaint with OSHA’s standards on Bloodborne Pathogens (29 CFR 1910.1030), Personal Protective Equipment (PPE) (1910.132), Respiratory Protection (1910.134), and other requirements.
Monkeypox is a viral illness that typically presents flu-like symptoms, exhaustion, body aches, swelling of the lymph nodes, and a painful rash of fluid-filled bumps. Symptoms appear within three weeks of exposure to the virus with the rash developing a few days later. Monkeypox could be confused with other transmissible pathogens like chickenpox, so a medical evaluation is important. Most people with monkeypox recover in 2-4 weeks; however, it can be extremely serious. Although no deaths related to the monkeypox virus have been reported in the US to date, immunocompromised people, pregnant women, and children are at a much greater risk of serious complications.
Protecting the workforce
Protecting workers is as simple as 1-2-3. Employers should ensure workers follow these guidelines:
- Avoid close, skin-to-skin contact with individuals with a rash that looks like monkeypox.
- Avoid contact with object and materials that an individual with monkeypox has used.
- Practice effective personal hygiene and workplace sanitation.
Avoiding close contact may be harder than workers think, as we tend to greet coworkers with handshakes or congratulate with pats on the back. Employers need to educate employees about the risks of exposure to the monkeypox virus while maintaining respect for everyone at the same time. Similarly, workers need to be more cognizant of handling or sharing PPE, jackets, utensils, or other items handled by a person with an outbreak.
Hygiene and sanitation
Hand hygiene, consisting of washing with soap and warm water for several seconds, has been cited as the single most important practice to reduce the transmission of infectious agents. This is especially important prior to eating, touching your face, and after using the bathroom. In the absence of soap and water, approved alcohol-based products for hand disinfection are acceptable followed with washing as soon as soap and water are available. Hand hygiene following glove removal further ensures that the hands will not carry potentially infectious material that might have penetrated through unrecognized tears or that could contaminate the hands during glove removal.
Disinfection and sanitation begin by ensuring employees avoid activities that could spread dried material from lesions (e.g., use of fans, dry dusting, sweeping, etc.) in areas where people with monkeypox have been. EPA-approved disinfectants should be used, and manufacturer’s directions followed for concentration, contact time, storage, and handling. Any contaminated materials and PPE must be disposed of properly.
Encourage open communication
It is vital that employers avoid stigmas and encourage open communication with workers that may have or have been exposed to the monkeypox virus. Information of the individual should remain confidential as with any situation involving personal medical information; however, general safety protocols can be put in place and communicated to the workforce to protect everyone. Cases should also be reported to public health officials to help identify exposure and prevent additional cases.
Key to remember
Monkeypox is the next public health challenge that is likely to infiltrate the workplace in a matter of time. Employers must be prepared to protect workers from exposures to this contagious pathogen. Having a proactive plan with procedures guiding workers on close interaction, sanitation, and open communication will ensure the safety of workers while remaining compliant with OSHA and other regulatory requirements.
NewsIndustry NewsInfectious DiseasesBloodborne PathogensInfectious DiseasesIn-Depth ArticleBloodborne PathogensEnglishFocus AreaUSA
Monkeypox cases are on the rise: Are your workers protected?
2022-08-15T05:00:00Z
Written by
Tricia Hodkiewicz
Tricia Hodkiewicz
Compliance Expert with extensive experience in OSHA/EPA regulations and a focus on safety plans, signs, BBP, HazCom, and EPCRA. Creates EHS content, delivers news, presents webcasts, and fields compliance questions.
Monkeypox is on the rise, demanding employers take action to protect their workers from exposure. Employers must ensure a workplace free of recognized hazards, including pathogens like monkeypox. Protecting workers requires developing, implementing, and communicating a plan with specific procedures that includes worker interactions, personal hygiene, and sanitation of facilities.
As of August 10, 2022, the Center for Disease Control (CDC) reported a rise of monkeypox to 10,392 total confirmed cases in the United States, an increase from only one in May of 2022. As the CDC monitors and responds to this rapidly spreading threat, employers should also. Proactive monitoring and response ensure employers are complaint with OSHA’s standards on Bloodborne Pathogens (29 CFR 1910.1030), Personal Protective Equipment (PPE) (1910.132), Respiratory Protection (1910.134), and other requirements.
Monkeypox is a viral illness that typically presents flu-like symptoms, exhaustion, body aches, swelling of the lymph nodes, and a painful rash of fluid-filled bumps. Symptoms appear within three weeks of exposure to the virus with the rash developing a few days later. Monkeypox could be confused with other transmissible pathogens like chickenpox, so a medical evaluation is important. Most people with monkeypox recover in 2-4 weeks; however, it can be extremely serious. Although no deaths related to the monkeypox virus have been reported in the US to date, immunocompromised people, pregnant women, and children are at a much greater risk of serious complications.
Protecting the workforce
Protecting workers is as simple as 1-2-3. Employers should ensure workers follow these guidelines:
- Avoid close, skin-to-skin contact with individuals with a rash that looks like monkeypox.
- Avoid contact with object and materials that an individual with monkeypox has used.
- Practice effective personal hygiene and workplace sanitation.
Avoiding close contact may be harder than workers think, as we tend to greet coworkers with handshakes or congratulate with pats on the back. Employers need to educate employees about the risks of exposure to the monkeypox virus while maintaining respect for everyone at the same time. Similarly, workers need to be more cognizant of handling or sharing PPE, jackets, utensils, or other items handled by a person with an outbreak.
Hygiene and sanitation
Hand hygiene, consisting of washing with soap and warm water for several seconds, has been cited as the single most important practice to reduce the transmission of infectious agents. This is especially important prior to eating, touching your face, and after using the bathroom. In the absence of soap and water, approved alcohol-based products for hand disinfection are acceptable followed with washing as soon as soap and water are available. Hand hygiene following glove removal further ensures that the hands will not carry potentially infectious material that might have penetrated through unrecognized tears or that could contaminate the hands during glove removal.
Disinfection and sanitation begin by ensuring employees avoid activities that could spread dried material from lesions (e.g., use of fans, dry dusting, sweeping, etc.) in areas where people with monkeypox have been. EPA-approved disinfectants should be used, and manufacturer’s directions followed for concentration, contact time, storage, and handling. Any contaminated materials and PPE must be disposed of properly.
Encourage open communication
It is vital that employers avoid stigmas and encourage open communication with workers that may have or have been exposed to the monkeypox virus. Information of the individual should remain confidential as with any situation involving personal medical information; however, general safety protocols can be put in place and communicated to the workforce to protect everyone. Cases should also be reported to public health officials to help identify exposure and prevent additional cases.
Key to remember
Monkeypox is the next public health challenge that is likely to infiltrate the workplace in a matter of time. Employers must be prepared to protect workers from exposures to this contagious pathogen. Having a proactive plan with procedures guiding workers on close interaction, sanitation, and open communication will ensure the safety of workers while remaining compliant with OSHA and other regulatory requirements.
See More
RELATED NEWS
NewsIn-Depth ArticleUSAHR ManagementEnglishIndustry NewsFleet SafetyInfectious DiseasesSafety & HealthConstruction SafetyInfectious DiseasesGeneral Industry SafetyAgriculture SafetyMaritime SafetyFocus AreaMine SafetyTransportationHuman Resources
09/26/2024
Bird Flu and Monkey Pox: Keeping outbreaks out of the workplace

Specialized Industries
Go beyond the regulations! Visit the Institute for in-depth guidance on a wide range of compliance subjects in safety and health, transportation, environment, and human resources.
J. J. Keller® COMPLIANCE NETWORK is a premier online safety and compliance community, offering members exclusive access to timely regulatory content in workplace safety (OSHA), transportation (DOT), environment (EPA), and human resources (DOL).

Interact With Our Compliance Experts
Puzzled by a regulatory question or issue? Let our renowned experts provide the answers and get your business on track to full compliance!

Upcoming Events
Reference the Compliance Network Safety Calendar to keep track of upcoming safety and compliance events. Browse by industry or search by keyword to see relevant dates and observances, including national safety months, compliance deadlines, and more.
SAFETY & COMPLIANCE NEWS
Keep up with the latest regulatory developments from OSHA, DOT, EPA, DOL, and more.
REGSENSE® REGULATORY REFERENCE
Explore a comprehensive database of word-for-word regulations on a wide range of compliance topics, with simplified explanations and best practices advice from our experts.
THE J. J. KELLER INSTITUTE
The Institute is your destination for in-depth content on 120+ compliance subjects. Discover articles, videos, and interactive exercises that will strengthen your understanding of regulatory concepts relevant to your business.
ADD HAZMAT, ENVIRONMENTAL, & HR RESOURCES
Unlock exclusive content offering expert insights into hazmat, environmental, and human resources compliance with a COMPLIANCE NETWORK EDGE membership.
DIRECT ACCESS TO COMPLIANCE EXPERTS
Struggling with a compliance challenge? Get the solution from our in-house team of experts! You can submit a question to our experts by email, set up a phone or video call, or request a detailed research report.
EVENTS
Register to attend live online events hosted by our experts. These webcasts and virtual conferences feature engaging discussions on important compliance topics in a casual, knowledge-sharing environment.
Most Recent Highlights In Environmental
NewsIndustry NewsIndustry NewsAir ProgramsAir EmissionsEnvironmental Protection Agency (EPA)CAA ComplianceEnvironmentalAir PermittingFocus AreaEnglishAir ProgramsStationary Emission SourcesUSA
2026-06-01T05:00:00Z
EPA restores emergency-related affirmative defense provisions for Title V operating permits
In response to a court mandate, the Environmental Protection Agency (EPA) has rescinded a 2023 final rule that removed emergency-related affirmative defense provisions from the Title V operating permit regulations (the 2023 Affirmative Defense Rule) under the Clean Air Act.
The final rule (published on June 1, 2026) reinstates the emergency-related affirmative defense provisions for state and federal Title V operating permit programs (at 40 CFR 70.6(g) and 71.6(g), respectively).
Who’s impacted?
EPA’s final rule affects stationary sources subject to Title V operating permit requirements.
What does this mean?
The emergency-related affirmative defense provisions establish a framework for regulated facilities to assert an affirmative defense in enforcement proceedings for violations of technology-based emission limits caused by sudden, unavoidable emergencies, provided certain conditions are met.
To rely on the emergency-related affirmative defense, stationary sources must demonstrate that:
- A qualifying emergency occurred,
- The facility was being properly operated,
- The facility took all reasonable actions to limit excess emissions, and
- The facility properly notified the permitting authority.
EPA’s demonstration requirements are listed at 70.6(g)(3)/71.6(g)(3).
What affirmative defense covers
An “emergency,” as defined by 70.6(g)(1)/71.6(g)(1), generally refers to a sudden, unforeseeable event beyond the facility’s control that causes noncompliance with technology-based emission limits established in its Title V operating permit.
What affirmative defense doesn’t cover
The provisions don’t apply to noncompliance due to:
- Improperly designed equipment,
- Lack of preventive maintenance,
- Careless or improper operation, or
- Operator error.
Key to remember: EPA has restored the emergency-related affirmative defense provisions for Title V operating permits, allowing stationary sources to assert a regulatory affirmative defense for certain emission violations caused by events beyond the facility’s control.
NewsIndustry NewsSustainabilityIn-Depth ArticleSustainabilityWaste MinimizationEnvironmentalEnglishSustainabilityFocus AreaUSA
2026-05-29T05:00:00Z
Water reuse: Put your facility’s wastewater to work
Did you know that one entity’s wastewater may be another organization’s treasure? Through water reuse, businesses reclaim municipal and industrial stormwater and wastewater, treat it to make it safe, and repurpose it for beneficial uses.
Reusing water can help companies lower costs, secure a more reliable water supply, and reduce environmental impact. While water reuse is usually voluntary, it must align with federal discharge requirements and state reuse regulations.
The Environmental Protection Agency (EPA) recently launched Water Reuse Action Plan (WRAP) 2.0, an initiative that seeks to advance water reuse in the industrial, technology, and energy sectors. Published in May 2026, Water Reuse Action Plan 2.0: Multiplying Water Benefits, Maximizing American Prosperity provides a comprehensive overview of WRAP 2.0, including specific case studies of how entities have improved operational efficiency by reusing water.
Let’s look at three of these successful water reuse examples and consider factors to help you determine whether water reuse can benefit your business.
Real-world examples of water reuse
Water reuse has been successfully integrated into operations across a range of industries by all types of businesses (from local car washes to national food production companies).
Automobile manufacturing
Painting uses more water than other processes in automobile manufacturing. One major vehicle manufacturer has addressed this through water reuse. At one of its Kentucky assembly plants, the manufacturer started reusing treated wastewater in the paint pretreatment process.
As a result, the assembly plant sends less wastewater to the publicly owned treatment works, uses less freshwater in the manufacturing process, and achieves cost savings by purchasing less water. For instance, during the first year of implementation, the water reuse initiative saved the plant about $50,000.
Stadium operations
A large stadium in Georgia contains a stormwater management system, including a cistern that catches rainwater runoff from the stadium’s roof and plaza structure. The stadium uses this rainwater runoff for exterior landscape irrigation and for make-up water for its cooling towers.
Additionally, nearly all of the plumbing fixtures installed in the stadium are low-flow fixtures, using less water than traditional fixtures.
Similar to the automobile manufacturer, reusing water means that the stadium purchases less water. The stadium’s water reuse efforts have also helped the facility secure a reputation for sustainability.
Refinery processing
A major refinery in California partners with the municipal utility district to reuse recycled water for its boilers.
Boilers require high-purity water, so the utility treats the recycled water with specific technologies (including reverse osmosis) to meet the quality standards. The utility treats the wastewater on-site, supplying the refinery with the recycled water. The refinery then uses the water in its boilers to generate steam needed to manufacture gasoline, diesel, and other products.
By reusing water, the refinery greatly reduces the amount of freshwater it uses (and therefore, reduces the cost of purchasing water). It also allows the refinery to continue operations during drought restrictions, making it more resilient to weather-related changes.
How’s water reuse regulated?
Water reuse is generally voluntary; however, it operates within existing regulatory frameworks that govern wastewater discharges and water quality.
Most states regulate water reuse, although some programs may be implemented at the local level. In California, for instance, the Regional Water Quality Control Boards issue water reuse permits in their respective covered areas, whereas the Texas Commission on Environmental Quality (a state agency) regulates water reuse projects.
Tip: Use EPA’s REUSExplorer tool to find water reuse guidelines or regulations for your facility’s state.
Can water reuse benefit your business?
Each company must evaluate its operational processes to determine whether water reuse can help improve efficiency. Use these tips as a starting point:
- First, assess existing processes to determine whether and how water can be reused.
- Estimate the costs of implementing water reuse projects, such as installing or upgrading the facility’s equipment or infrastructure.
- Compare the potential benefits to the associated costs of reusing water. Consider both the short-term and long-term effects.
- Confirm the compliance requirements for water reuse with the proper regulatory authority (generally, the state environmental agency).
Water reuse may offer your business the opportunity to put its wastewater to work.
Key to remember: Water reuse implemented in compliance with applicable regulations can help facilities improve operational efficiency, lower costs, and reduce environmental impact.
NewsGreenhouse GasesIndustry NewsIndustry NewsEnvironmental Protection Agency (EPA)CAA ComplianceEnvironmentalFocus AreaEnglishAir ProgramsAir ProgramsUSA
2026-05-27T05:00:00Z
Final rule revises HFC use restrictions and compliance timelines for specific subsectors
On May 26, 2026, the Environmental Protection Agency (EPA) finalized a rule (2026 Final Rule) revising regulations on the use of hydrofluorocarbons (HFCs) in certain subsectors. The final rule specifically amends requirements established by the 2023 Technology Transitions Rule under the American Innovation and Manufacturing Act of 2020 (AIM Act).
EPA also published a proposed rule to exempt road and intermodal container transport refrigeration units (TRUs) from leak repair requirements set by the 2024 Emissions Reduction and Reclamation (ER&R) Rule.
Who’s impacted?
The 2026 Final Rule applies to entities that are subject to the 2023 Technology Transition Rule requirements (40 CFR 84.54) for these subsectors:
- Refrigerated transport — intermodal containers,
- Industrial process refrigeration (IPR) and chillers for IPR used in semiconductor manufacturing,
- Retail food — supermarket systems,
- Retail food — remote condensing units,
- Cold storage warehouses,
- Residential and light commercial air conditioning and heat pumps (RACHP), and
- IPR (not using chillers) — refrigerated laboratory centrifuges and refrigerated laboratory shakers.
The 2026 proposed rule applies to refrigerant-containing road and intermodal container transport refrigeration units (TRUs) regulated by the 2024 ER&R Rule.
What are the changes?
The 2026 Final Rule:
- Adjusts the lower bound temperature and measurement location for refrigerated transport intermodal containers from -50°C to -35°C;
- Extends the compliance dates to January 1, 2030, for restrictions on uses of HFCs and HFC blends by IPR and chillers for IPR in semiconductor manufacturing process equipment (limited to equipment with a charge size of 100 pounds or less);
- Allows retail food supermarket systems to increase the cooling capacity of existing systems by up to 15 percent without triggering new installation requirements;
- Establishes temporary, relaxed interim global warming potential (GWP) limits (implementing stricter GWP limits starting on January 1, 2032) for:
- Retail food supermarket systems,
- Retail food remote condensing unit systems, and
- Cold storage warehouses.
- Allows RACHP equipment using specific components that were domestically manufactured or imported before January 1, 2025, to continue to be installed; and
- Delays the compliance dates to January 1, 2028, for restrictions on uses of HFCs and HFC blends by refrigerated laboratory centrifuges and refrigerated laboratory shakers.
Please note that the final rule states that EPA maintains existing requirements for new condensing units used as replacements in the RACHP subsector.
What’s the proposed rule?
The 2024 ER&R Rule added leak repair requirements (84.106) for refrigerant-containing appliances with a charge size of 15 pounds or more containing an HFC or a specific HFC substitute, which took effect on January 1, 2026. Examples of the requirements include leak inspections, appliance repairs, and reporting.
EPA proposes to exempt all refrigerant-containing road and intermodal container TRUs from the leak repair provisions (regardless of charge size).
Key to remember: EPA has issued a final rule revising HFC use restrictions for certain subsectors and has proposed a rule exempting transportation refrigeration units from leak repair requirements.
NewsEnforcement and Audits - OSHAPesticidesWorker Protection from PesticidesIn-Depth ArticleHazard CommunicationHR ManagementEnglishUSAIndustry NewsOSHA InspectionsSafety & HealthContingent WorkforceConstruction SafetyGeneral Industry SafetyAgriculture SafetyMaritime SafetyEnvironmentalHazard CommunicationTemporary EmployeesFocus AreaPesticidesHuman Resources
2026-05-26T05:00:00Z
OSHA packs new HazCom directive with enforcement clues
The first compliance date for the amended Hazard Communication (HazCom) standard has arrived, and OSHA finally issued its updated directive. The CPL instructs OSHA officers on how to conduct inspections and issue citations under the standard. However, it also provides chemical manufacturers, importers, distributors, and employers with insight into what officers will be assessing.
In effect, this CPL translates regulatory text into inspector expectations. It shows what adherence to the standard looks like in practice. That makes it a critical resource given recent and upcoming dates at 29 CFR 1910.1200(j).
CPL rewritten for the 2024 standard
On May 19, 2026, OSHA posted a revised CPL 02-02-079, “Inspection Procedures for the Hazard Communication Standard (HCS 2024),” replacing the July 9, 2015, version. The 132-page document reflects the reconfigured HazCom standard published May 20, 2024, effective on July 19, 2024, along with corrections issued through early 2026.
The agency designed this enforcement playbook to maintain uniform inspections during the transition period and after full implementation. Because of the extensive regulatory changes to definitions, hazard classification, labeling, safety data sheets, and trade secrets, the CPL is not a light refresh.
For those familiar with the rulemaking, the new CPL edits will not be surprising. Still, the directive should provide more clarity than the regulatory text.
Front matter and appendices
Updates to Sections I to IX are typical of a CPL, including:
- Cancellation of the 2015 CPL;
- A modified title and references to the 2024 final rule and corrections;
- Alignment with revisions 7 and 8 of the United Nations Globally Harmonized System of Classification and Labelling of Chemicals (GHS); and
- A new summary of changes, historical background, and compliance dates.
OSHA also modernized appendices for dates, hazard lists, pictogram hazards, SDS review guidance, chemical resources, and related directives.
Reworked inspection guidelines
Section X outlines inspector instructions for paragraphs (b) through (j) of the standard. The latest modifications impact most sections:
- Scope, applicability, and exemptions — The directive offers new examples and expanded explanations, such as:
- A formaldehyde hazard example for hair smoothing products;
- An overview of pesticide labeling requirements and exemptions;
- Discussion of the EPA Agricultural Worker Protection standard preemption; and
- Greater detail about biological hazards from plants.
- Definitions — The document introduces terms and explains bulk shipment, immediate outer package, physical hazard, released for shipment, and more. It also revisits the terms combustible dust and manufacturer. Lithium-ion batteries are now referenced in the distributor context.
- Hazard classification — The directive instructs OSHA officers to consider the classification of:
- Hazards associated with a chemical’s intrinsic properties, including changes in physical form and reactions from known or reasonably anticipated uses; and
- Impurities, additives, and individual constituents.
- Written plan — The directive clarifies:
- Employers must revise programs by the compliance dates when new information is received from suppliers;
- The use of computers and third-party administrators of safety data sheets (SDSs); and
- The written program must describe how employees will be trained in a language and at a literacy level they understand.
- Labeling — The directive broadens the sections on Department of Transportation labeling, bulk shipments, and small container labeling. It incorporates final rule flexibility too:
- Phased-in compliance dates for labeling;
- Hazards not otherwise classified (HNOCs) and hazards identified and classified under 1910.1200(d)(1)(ii) don’t need to be addressed on the container;
- The exclamation mark pictogram is permitted (but not required) for HNOCs, under certain conditions;
- Minor textual variations for precautionary statements are allowed; and
- OSHA offers alternatives for chemical containers released for shipment.
- Safety data sheets (SDSs) — Amended text focuses on U.S. jurisdiction and technical provisions, such as:
- Phased-in compliance dates for SDSs;
- Importer SDS responsibilities;
- Using a U.S. address and phone number;
- The hazard class and category reflecting intrinsic properties;
- Required Chemical Abstracts Service (CAS) number or other unique identifiers; and
- No need to obtain updated SDSs to replace already received SDSs.
- Employee information/training — The directive references a temporary workers bulletin. It also emphasizes:
- Phased-in compliance dates for necessary training adjustments; and
- Delivering training in a language employees understand.
- Trade secrets — The instruction aligns with the 2024 rule:
- Allows the exact percentage, exact concentration range, or CAS number to be withheld if certain criteria are met; and
- Addresses the use of confidentiality agreements.
- Dates — The directive overhauls compliance timelines and discusses documentation of due diligence and good faith efforts.
In addition, the directive softens citation language with phrases like “should normally cite” instead of “shall cite.” This shift suggests inspectors may have greater discretion based on case-specific circumstances.
Key to remember
While 1910.1200 remains the baseline for employers and chemical manufacturers, importers, and distributors, the revised CPL 02-02-079 provides an enforcement lens. With implementation underway, regulated entities can use the CPL to steer their efforts and conform with how OSHA will inspect them in the field.
NewsIndustry NewsSafety & HealthGeneral Industry SafetyIndoor Air QualityIndustrial HygieneCAA ComplianceEnvironmentalIn-Depth ArticleEnglishFocus AreaUSA
2026-05-22T05:00:00Z
Where workplace exposure meets air permitting: Bridging OSHA industrial hygiene and EPA air programs
Air quality inside a facility and emissions leaving a stack are closely linked. The same chemicals that drive occupational exposure limits under the Occupational Safety and Health Administration (OSHA) often form the basis of regulated air pollutants under the Environmental Protection Agency's (EPA's) programs.
When industrial hygiene (IH) and environmental compliance teams work together, they can spot risks sooner, strengthen controls, and avoid surprises in permits or inspections. The overlap is practical. Worker exposure data can inform stack testing, and permit conditions can signal where IH monitoring should focus.
Shared chemistry, different lenses
Both programs start with the same substances, such as solvents, metals, acids, and combustion byproducts. IH focuses on what workers breathe in the workplace. It uses exposure limits such as OSHA permissible exposure limits or more protective guidelines from the National Institute for Occupational Safety and Health (NIOSH) and the American Conference of Governmental Industrial Hygienists (ACGIH). Environmental air programs focus on what leaves the property. They regulate criteria pollutants, hazardous air pollutants (HAPs), and toxics using emission limits, control requirements, and reporting rules.
The data tools look similar. IH uses personal and area sampling, direct-reading instruments, and task-based assessments. Environmental programs use emission factors, mass balance, continuous monitoring, and periodic stack testing. Both require documentation, quality control, and records.
Key differences that matter
The point of exposure is the biggest difference. IH evaluates the breathing zone of a worker during a task or shift. Environmental programs measure emissions at a release point, such as a stack, or estimate them across the site.
The time frame also differs. IH often looks at short-term peaks and full-shift averages to protect health during work. Air permits may set hourly, daily, or annual limits, and they may cap total emissions per year. Control strategies follow these goals. IH may rely on local exhaust ventilation, enclosure, or work practice changes. Air permits may require add-on controls such as thermal oxidizers, scrubbers, or filters.
Practical crossover: Using IH to inform permitting
IH data can reveal which tasks generate the highest concentrations and which compounds dominate exposure. That insight can refine emission estimates. For example, if wipe cleaning with a solvent produces the highest worker exposure, the same solvent may drive facility-wide volatile organic compound (VOC) emissions. The environmental team can use that knowledge to prioritize accurate emission factors, refine mass balance, or plan stack testing during peak operations.
IH data also helps define realistic operating scenarios for compliance testing. Stack tests that occur only at typical loads may miss worst-case conditions. Pairing test timing with identified peak tasks can provide a more representative test and reduce the risk of later noncompliance.
Practical crossover: Using permits to inform IH
Air permits define regulated compounds, control devices, and operating limits. These details can guide IH planning. If a permit lists specific HAPs or requires a control device for a process, there's a clear signal that exposure to those compounds is possible near the source. IH can target those areas for baseline sampling, validate control performance, and confirm that capture systems are effective where workers are present.
Permit conditions also flag upset and startup modes. These periods can increase emissions. IH can align monitoring during these windows to assess short-term exposures and ensure that work practices and protective measures are adequate.
Aligning controls for dual benefit
Engineering controls can serve both goals when designed as a system. Capture at the source reduces worker exposure and lowers emissions to the stack. Good enclosure and balanced ventilation improve control efficiency and reduce fugitive releases. Preventive maintenance on control devices supports permit limits and keeps workplace air clean.
Administrative controls can align as well. Standard operating procedures can link production rates, control device settings, and ventilation checks. Change management should include both an IH review and an air permitting check to see if a modification triggers a permit update.
Communication and workflows
Successful crossover depends on routine communication. Regular meetings enable safety and environmental staff to share results, plan sampling, and coordinate testing windows. Shared inventories of chemicals and processes reduce duplication and errors. A common data platform, or at least a consistent file structure, makes it easier to compare IH results with emission estimates and permit limits.
Clear triggers help teams act. Examples include a new chemical introduction, a process change, a spike in IH results, or a deviation in control device performance. Each trigger should prompt both an IH review and an environmental compliance check.
Key to remember: When teams connect their data and plans, they gain a clearer picture of risk. The results are stronger compliance, better worker protection, and more efficient operations.
Most Recent Highlights In Transportation
NewsIndustry NewsIndustry NewsToxic Substances Control Act - EPAToxic Subtances Control Act - EPATSCA ComplianceEnvironmental Protection Agency (EPA)EnvironmentalEnglishFocus AreaUSA
2026-05-22T05:00:00Z
Final rule extends TSCA Section 8(d) health and safety reporting deadline
The Environmental Protection Agency (EPA) issued a final rule on May 22, 2026, extending the reporting deadline for the Toxic Substances Control Act (TSCA) Section 8(d) Health and Safety Data Reporting Rule from May 22, 2026, to May 21, 2027.
Who’s impacted?
The TSCA Section 8(d) Health and Safety Data Reporting Rule applies to manufacturers (including importers) of any of the 16 chemical substances listed at 40 CFR 716.120(d), including:
- Entities that currently manufacture (including import) any of the chemicals; and
- Entities that have manufactured (including imported) or have proposed to manufacture (including import) any of the chemicals since January 13, 2015.
What’s required?
The rule requires covered manufacturers (including importers) to submit a one-time report of data on the chemicals from unpublished studies on:
- Health and safety;
- Environmental effects; and
- Occupational, general population, and consumer exposure.
Which chemicals are covered?
The TSCA Section 8(d) Health and Safety Data Reporting Rule applies to:
|
|
Why the delay?
EPA has extended the deadline to allow additional time to reconsider the rule’s scope and possibly propose revisions to the regulations. Once any major changes are finalized, EPA will communicate the updated reporting requirements and timelines accordingly.
Key to remember: EPA has extended the submission date for the TSCA Section 8(d) Health and Safety Data Reporting Rule’s one-time report to May 2027.
NewsIndustry NewsIndustry NewsSafe Drinking WaterWater ProgramsWater QualityEnvironmental Protection Agency (EPA)Maximum Contaminant LevelsEnvironmentalUSAWater ProgramsEnglishFocus AreaCWA Compliance
2026-05-20T05:00:00Z
EPA floats major changes to current PFAS drinking water rules
The Environmental Protection Agency (EPA) has released two proposed rules that, if finalized, would have major impacts on drinking water regulations for per- and polyfluoroalkyl substances (PFAS), specifically, the 2024 National Primary Drinking Water Regulation (NPDWR) for PFAS (2024 PFAS NPDWR).
Proposed rule: MCL compliance extension
The first rule proposes to establish a federal exemption that allows public water systems (PWSs) to request an extension of the deadline to comply with the Maximum Contaminant Levels (MCLs) for perfluorooctanoic acid (PFOA) and perfluorooctane sulfonic acid (PFOS) from April 26, 2029, to April 26, 2031.
The rule would require PWSs that meet the eligibility requirements to submit a request to EPA for the federal exemption within 180 days of the date a final rule is published. PWSs would have to provide specific information in the request (such as recent water sample results and a certified statement that the system can’t comply with the original MCL deadline).
Additionally, EPA’s proposed rule would require:
- All PWSs with the federal exemption to notify customers of the exemption, and
- PWSs with PFOA or PFOS levels at or above 12 parts per trillion to implement two control measures (from six options) during the exemption period.
Who would be impacted?
The proposed federal exemption would apply to PWSs:
- Regulated by the 2024 PFAS NPDWR for PFOA and PFOS;
- In operation on or before June 25, 2024;
- Not under a variance for small systems for the PFOA and PFOS MCLs; and
- In a state that doesn’t have primacy for the 2024 PFAS NPDWR.
PWSs in states with primacy for the 2024 PFAS NPDWR may request an exemption from the primacy agency.
Proposed rule: Rescinding PFAS NPDWRs
The second rule proposes to rescind EPA’s determinations to regulate:
- Perfluorohexane sulfonic acid (PFHxS);
- Perfluorononanoic acid (PFNA);
- Hexafluoropropylene oxide dimer acid and its ammonium salt (HFPO-DA, called GenX chemicals); and
- Perfluorobutane sulfonic acid (PFBS).
It also proposes to remove the related 2024 PFAS NPDWR provisions from 40 CFR Parts 141 and 142, including:
- The MCLs and MCL Goals (MCLGs) for PFHxS, PFNA, and HFPO-DA;
- The MCL and MCLG for mixtures with two or more of PFHxS, PFNA, HFPO-DA, and PFBS (referred to as the Index PFAS); and
- All other compliance requirements.
The proposed rule would maintain the 2024 PFAS NPDWR requirements for PFOA and PFOS.
Who would be impacted?
The rule would impact PWSs, including community water systems (CWSs) and non-transient non-CWSs, subject to the 2024 PFAS NPDWR standards for PFHxS, PFNA, HFPO-DA, or the Index PFAS.
How do I give feedback?
EPA will hold a virtual public hearing for verbal comments on the proposed rules on July 7, 2026. Written comments for the proposed compliance extension rule (Docket ID No. EPA-HQ-OW-2025-1742) and proposed rescission rule (Docket ID No. EPA-HQ-OW-2025-0654) are due by July 20, 2026.
Key to remember: EPA has proposed major changes to the national drinking water regulations for PFAS.
NewsRecyclingChange NoticesChange NoticeCaliforniaSustainabilityEnvironmentalProduct StewardshipEnglishSustainabilityFocus Area
2026-05-20T05:00:00Z
California approves plastic packaging regulations
Effective date: May 1, 2026
This applies to: Producers of single-use packaging and plastic single-use food service ware
Description of change: CalRecycle approved permanent regulations to implement the Plastic Pollution Prevention and Packaging Producer Responsibility Act (SB 54). The regulations require producers of covered materials (single-use packaging and plastic single-use food service ware) to administer an extended producer responsibility program.
Producers must meet minimum recycled content requirements for covered materials and pay fees (including annual mitigation surcharges for all producers and fees to producers participating in a producer responsibility organization (PRO) plan).
By June 1, 2026, producers must:
- Register with Circular Action Alliance (CAA) and submit supply data to CAA if participating in an approved PRO plan,
- Register with CalRecycle and apply to be an independent producer if complying individually, or
- Register with CalRecycle and apply for the small producer exemption if qualified.
NewsToxic Substances Control Act - EPANew MexicoNew Mexico Environment Department (NMED)Change NoticesTSCA ComplianceChange NoticeToxic Substances - EPAEnvironmentalEnglishFocus Area
2026-05-20T05:00:00Z
New Mexico adopts PFAS product phaseout regulations
Effective date: July 1, 2026
This applies to: Manufacturers, distributors, and retailers that sell, offer for sale, distribute, or distribute for sale products that contain intentionally added per- and polyfluoroalkyl substances (PFAS) in New Mexico
Description of change: The New Mexico Environment Department adopted regulations implementing the PFAS Protection Act (HB212), which phases out consumer products with intentionally added PFAS. The regulations contain:
- The prohibitions of products (with specific product categories and timelines),
- Reporting and testing requirements,
- Labeling requirements, and
- Fees for mandatory reporting and “currently unavoidable use” designation applications.
The regulations establish three phaseout deadlines:
- The first group of products must be phased out by January 1, 2027.
- The second group of products must be phased out by January 1, 2028.
- All other nonexempt products and products without currently unavoidable use designations must be phased out by January 1, 2032.
NewsPublicly Owned Treatment WorksWater ProgramsWater QualityWater ProgramsStormwaterEnglishCWA ComplianceMunicipal WastewaterPoint SourcesChange NoticesChange NoticeCaliforniaIndustrial WastewaterEnvironmentalFocus Area
2026-05-20T05:00:00Z
California adopts risk-based water quality standards for nonpotable water
Effective date: April 22, 2026
This applies to: Owners and operators of on-site treated nonpotable water systems (OTNWS)
Description of change: The California State Water Resources Control Board adopted risk-based water quality standards that apply to OTNWS for the on-site treatment and reuse of nonpotable water for nonpotable end uses in:
- Multifamily residential buildings,
- Commercial buildings, and
- Mixed-use buildings.
The types of nonpotable water include on-site:
- Wastewater,
- Graywater,
- Stormwater, and
- Roof runoff.
The regulations apply to indoor and outdoor nonpotable uses, including:
- Toilet and urinal flushing,
- Drain trap priming,
- Clothes washing,
- Decorative fountains,
- Landscape irrigation,
- Ornamental plant irrigation,
- Dust suppression, and
- Car washing.
Related state info: Industrial water permitting — California
Most Recent Highlights In Safety & Health
NewsWater ProgramsEnvironmental Protection Agency (EPA)Mobile Emission SourcesCAA ComplianceAir PermittingWater ProgramsCWA ComplianceEnglishAir ProgramsIndustry NewsIndustry NewsWater PermittingPoint SourcesCriteria Air PollutantsIndustrial WastewaterEnvironmentalFocus AreaAir ProgramsStationary Emission SourcesUSA
2026-05-19T05:00:00Z
EPA proposes major changes to multiple rules
The Environmental Protection Agency (EPA) has been on a rulemaking roll! In recent weeks, the agency has published significant proposed rules in the Federal Register that affect coal-fired power plant wastewater, pre-construction air permits, and vehicle emission requirements.
Coal-fired power plants: Unmanaged CRL discharges
EPA proposes to revise the wastewater requirements established by a 2024 final rule (2024 Rule) for unmanaged combustion residual leachate (CRL) from coal-fired power plants.
Unmanaged CRL (a type of waste stream) is water that contains coal combustion residuals and leaks from landfills or surface impoundments (i.e., waste management units). Unmanaged CRL includes:
- Pumped unmanaged CRL (leached CRL that’s captured, pumped to the surface, and discharged directly to waters of the United States); and
- The functional equivalent of an unmanaged CRL direct discharge (determined by the permitting authority).
The proposed rule applies to coal-fired power plants with unmanaged CRL that are subject to the 2024 Rule’s technology-based effluent limitations guidelines and standards.
The agency proposes three options to revise the unmanaged CRL requirements:
- Option 1 (preferred by EPA) would maintain the 2024 rule’s mercury and arsenic numeric limits for pumped unmanaged CRL discharges, but it would delay the compliance deadline from December 31, 2029, to December 31, 2034. Additionally, the permitting authorities would determine best available technology economically achievable (BAT) limits for functional equivalents on a case-by-case basis.
- Option 2 would maintain the 2024 rule’s mercury and arsenic numeric limits for pumped unmanaged CRL discharges and functional equivalents. It would also maintain the original compliance timeline of December 31, 2029.
- Option 3 would impose zero-discharge limits for all pollutants in pumped unmanaged CRL discharges and functional equivalents. It would also establish interim BAT limits for mercury and arsenic. Facilities would have to meet the zero-discharge limits by December 31, 2034.
Public comments are due by June 17, 2026 (Docket ID No. EPA–HQ–OW–2009–0819).
Pre-construction air permits: Begin actual construction
EPA proposes to allow construction-related activities on components or structures that don’t emit air pollutants to start before obtaining a New Source Review (NSR) pre-construction permit to build or modify a stationary source. The proposed rule:
- Redefines “begin actual construction," and
- Adds “pollutant-emitting activities” to the regulatory definitions.
Both definitions list equipment, components, and processes that are excluded, meaning that construction on these activities may begin before obtaining an NSR permit. Examples of exempt activities include compacting and stabilizing soil, paving surfaces, and installing concrete pads.
If finalized, the proposed rule will distinguish between construction on stationary sources and construction on non-emitting components (e.g., utility infrastructure, certain building foundations) and codify that on-site construction of non-emitting components or structures can begin before getting an NSR permit.
Public comments are due by June 29, 2026 (Docket ID No. EPA-HQ-OAR-2025-0618).
Light- and medium-duty vehicle regulations: Tier 4 standards
EPA published Part 1 of a two-part rulemaking effort to revise the Tier 4 criteria air pollutant standards set in 2024 (Tier 4 Rule) for light- and medium-duty vehicles (LMDVs), which include:
- Light-duty vehicles and trucks,
- Medium-duty passenger vehicles, and
- Medium-duty vehicles.
In Part 1, EPA proposes to amend the phase-in schedule for Tier 4 criteria air pollutant requirements by:
- Extending the Tier 3 standards set in 2014 (Tier 3 Rule) for LMDVs to model years (MYs) 2027 and 2028,
- Delaying the start of phasing in Tier 4 standards for LMDVs from MY 2027 to MY 2029, and
- Removing the optional early phase-in of Tier 4 standards for LMDVs with a gross vehicle weight rating of more than 6,000 pounds from MYs 2027 and 2028.
The agency also proposes to delay changes to the test protocols for emissions performance certification evaluations to MY 2029.
In Part 2, EPA will reconsider the Tier 4 Rule for LMDVs, which may include changing emission standards, lead time and phase-in schedules, and test procedures.
Public comments are due by July 6, 2026 (Docket ID No. EPA–HQ–OAR–2025–3297).
Key to remember: EPA has issued a series of proposed rules that, if finalized, may have significant regulatory impacts on power plant wastewater, pre-construction air permits, and vehicle emission requirements.
NewsAir QualityIndustry NewsStationary Emission SourcesEnvironmental Protection Agency (EPA)Hazardous Air PollutantsCAA ComplianceEnvironmentalIn-Depth ArticleFocus AreaEnglishAir PermittingAir ProgramsAir ProgramsUSA
2026-05-14T05:00:00Z
MACT emission standards: 7 questions answered
Standards are more than just suggestions when it comes to environmental regulations; they define the minimum level of performance that must be achieved and, as a result, determine who complies and who doesn’t. For industrial facilities that release air toxics, emission standards are foundational to compliance.
The Environmental Protection Agency (EPA) controls the release of more than 180 air toxics, known as hazardous air pollutants (HAPs), from industrial sources (such as factories and refineries) through the National Emission Standards for Hazardous Air Pollutants (NESHAP) program. For major sources, EPA develops maximum achievable control technology (MACT) standards to reduce HAP emissions.
Understanding the basics of MACT standards can help you navigate the requirements specific to your facility. Here’s what you need to know.
What’s a MACT standard?
A MACT standard refers to the specific technology-based requirements set by EPA to control HAP emissions from major sources in a specific industrial source category. The agency bases the standards on the emission levels already being achieved with existing control technologies by the best-controlled and lowest-emitting facilities in an industry.
What’s a MACT floor?
MACT floors are the minimum control levels that regulated facilities must meet. EPA sets MACT floors differently for new and existing facilities:
- The MACT floors for new facilities must be at least as stringent as the emission control achieved by the best-controlled similar source.
- The MACT floors for existing facilities (which may be less stringent than the floors for new sources) have to be at least as strict as the average emission limitation achieved by either:
- The top-performing 12 percent of sources in a category or subcategory with 30 or more sources, or
- The top-performing 5 sources in a category or subcategory with fewer than 30 sources.
Keep in mind that EPA may establish requirements stricter than the MACT floor, known as “beyond-the-floor” standards.
What types of facilities are subject to MACT standards?
MACT standards generally apply to major sources of HAP emissions. A facility is considered a major source if it emits or has the potential to emit:
- 10 tons per year (tpy) of any one HAP, or
- 25 tpy of any combination of HAPs.
How are MACT standards organized?
EPA develops MACT standards by industry sector and publishes them as part of the NESHAP regulations. Most of the rules appear under 40 CFR Part 63, organized by subparts based on source category. Facilities must identify their source category to determine which NESHAP subpart applies.
A limited number of the rules are found under Part 61, organized by subparts based on specific HAPs (such as vinyl chloride) or activities (like asbestos demolition). Facilities need to confirm whether any of the NESHAPs for specific HAPs or activities apply.
How are MACT standards enforced?
The air permitting authority (usually a state or local air agency) incorporates applicable NESHAP requirements, including MACT standards, into a facility’s Title V operating permit.
What do MACT standards cover?
MACT standards can include a combination of measures, methods, processes, systems, and techniques to reduce or eliminate HAP emissions. Examples include:
- Conducting process changes;
- Substituting materials;
- Enclosing systems or processes; and
- Collecting, capturing, and/or treating HAP releases from emission points.
MACT standards may also contain design, equipment, work practice, and operation requirements.
Can MACT standards change?
Yes. The Clean Air Act requires EPA to evaluate MACT standards every 8 years (known as a risk and technology review). The agency will revise MACT standards when it determines improvements in technologies, practices, processes, or other emission-reduction methods warrant revisions.
Real-world example
Let’s take a look at the NESHAP for Polyether Polyols (PEPO) Production (PEPO NESHAP), recently updated in March 2026.
The MACT standards that apply to the PEPO NESHAP (Part 63 Subpart PPP) include:
- Emission limits for process vents;
- Equipment and work practice requirements for storage vessels, wastewater, and equipment leaks; and
- Work practice standards for heat exchange systems.
EPA concluded that improvements in controls warranted updates to specific MACT standards in the PEPO NESHAP, including for heat exchange systems. Specifically, the revised rule requires owners and operators of existing and new heat exchange systems in organic HAP service to:
- Conduct quarterly monitoring using the Modified El Paso Method (also known as the Air Stripping Method), and
- Repair leaks of total strippable hydrocarbon concentration (as methane) in the stripping gas of 6.2 parts per million by volume or greater.
The agency found that the Modified El Paso Method is more effective at identifying leaks, and it measures more compounds than previously required methods. As a result, this revised MACT standard will further reduce HAP emissions from heat exchange systems.
Key to remember: EPA controls hazardous air pollutant emissions from major sources through MACT standards based on the emission levels already achieved by the best-controlled facilities in an industry.
NewsGreenhouse GasesWaste/HazWasteToxic Substances Control Act - EPASafe Drinking WaterWater AnalysisWater ProgramsWater QualityMaximum Contaminant LevelsWalking Working SurfacesMonthly Roundup VideoCAA ComplianceSolid WasteCWA ComplianceLaddersEnglishUSAHeat StressIndustry NewsHeat and Cold ExposureSafety & HealthGeneral Industry SafetyWasteMaritime SafetyEnvironmentalFocus AreaWater MonitoringVolatile Organic CompoundsAir ProgramsStationary Emission SourcesVideo
EHS Monthly Round Up - April 2026
In this April 2026 roundup video, we’ll review the most impactful environmental health and safety news.
Hi everyone! Welcome to the monthly news roundup video, where we’ll review the most impactful environmental health and safety news. Let’s take a look at what happened over the past month.
OSHA revised its National Emphasis Program on heat-related hazards. Going forward, the agency will prioritize inspections in 55 high-risk industries in indoor and outdoor work settings. The program remains in effect for 5 years from its April 10 effective date.
An OSHA proposed rule seeks to eliminate the November 18, 2036, deadline in the Walking-Working Surfaces standard that would require all fixed ladders extending more than 24 feet above a lower level to be equipped with personal fall arrest systems or ladder safety systems. OSHA also seeks feedback on nine specific questions related to the proposal, with comments due on June 5.
On April 17, OSHA revoked its House Falls in Marine Terminals standard at 1917.41. The agency said that because most cargo has been containerized and is moved by cranes, the standard is no longer necessary to protect employees.
Turning to environmental news, an EPA final rule further delays the submission period for the one-time PFAS report required of manufacturers. It pushes the start of the submission period to either 60 days after the effective date of a future final rule updating the PFAS Reporting Rule or January 31, 2027, whichever comes first.
An EPA final rule makes technical changes to the emission standards established in March 2024 for crude oil and natural gas facilities. The changes take effect June 8.
EPA published the draft 6th Contaminant Candidate List for the next group of contaminants to be considered for regulation under the Safe Drinking Water Act. The proposed list designates microplastics and pharmaceuticals as priority contaminant groups for the first time.
And finally, EPA plans to make significant changes to coal combustion residuals requirements. A proposed rule published April 13 would revise the regulations governing the disposal of coal combustion residuals in landfills and surface impoundments, as well as the beneficial use of coal combustion residuals.
Thanks for tuning in to the monthly news roundup. We’ll see you next month!
NewsGreenhouse GasesEnforcement and Audits - OSHAMonthly Roundup VideoWalking Working SurfacesCAA ComplianceUSAInjury and Illness RecordkeepingLaddersEnglishIndustry NewsEnforcement and Audits - OSHAOSHA InspectionsSafety & HealthInjury and Illness Recording CriteriaGeneral Industry SafetyEnvironmentalFocus AreaAir ProgramsVideo
EHS Monthly Round Up - February 2026
In this Februrary 2026 roundup video, we'll discuss the most impactful environmental health and safety news.
Hi everyone! Welcome to the monthly news roundup video, where we’ll review the most impactful environmental health and safety news. Let’s take a look at what happened over the past month.
Fatal work injuries fell 4 percent in 2024, largely due to a decline in workplace drug- and alcohol-related overdoses. According to the Bureau of Labor Statistics, overdose fatalities fell from 512 in 2023 to 410 in 2024. Across all types of workplace incidents, there were 5,070 fatal work injuries in 2024, compared to 5,283 in 2023. Transportation incidents continue to be the most frequent type of fatal event, accounting for over 38 percent of all occupational fatalities in 2024.
OSHA is fast-tracking a proposal to remove the 2036 obligation to upgrade fall protection systems on fixed ladders that extend over 24 feet. This follows an industry petition from major chemical and petroleum industry groups, which argue the provision is unjustified, costly, and not supported by the rulemaking record. OSHA frames the upcoming proposed action as deregulatory, allowing employers to update fixed ladders at the end of their service lives. We’ll provide updates as more information becomes available.
As OSHA leans into “deregulatory” actions, lawmakers are moving to pressure the agency to issue “regulatory” rulemaking to protect American workers. The latest legislative wave of bills aims to fill regulatory gaps, tackle emerging hazards, expand OSHA authority, and raise penalties. Topics addressed by these bills include musculoskeletal disorders, heat stress, infectious diseases, wildfire smoke, and workplace violence.
In a recently issued letter of interpretation, OSHA states that a burn injury caused by a personal lithium-ion battery fire is work related if it occurs in the workplace during assigned working hours. The letter details an incident where an employee was burned when their rechargeable lithium-ion batteries for e-cigarettes sparked a fire after coming into contact with a key used for work.
A new report from the Department of Labor Office of Inspector General concludes that OSHA struggles to meet its mission, particularly in high-risk industries like healthcare, construction, and manufacturing. Several pages point to OSHA’s difficulties in effectively enforcing annual injury and illness reporting requirements, reaching the nation’s high-risk worksites for inspection, and addressing workplace violence by regulatory or other action.
Turning to environmental news, EPA extended the deadlines for Facility Evaluation Reports and related requirements for coal combustion residuals facilities. In most instances, the deadlines have been moved one or two years out.
And finally, EPA announced a final rule eliminating the 2009 Endangerment Finding and related greenhouse gas emission requirements for on-highway vehicles and vehicle engines. When the final rule takes effect, manufacturers and importers of new motor vehicles and motor vehicle engines will no longer have to measure, report, certify, or comply with federal greenhouse gas emission standards.
Thanks for tuning in to the monthly news roundup. We’ll see you next month!
NewsWaste ManifestsEnforcement and Audits - OSHAWaste/HazWasteWater ProgramsMonthly Roundup VideoCAA ComplianceUSACWA ComplianceStormwaterEnglishAir ProgramsIndustry NewsEnforcement and Audits - OSHAMunicipal WastewaterSafety & HealthGeneral Industry SafetyWasteEnvironmentalFocus AreaAir ProgramsVideo
EHS Monthly Round Up - March 2026
In this March 2026 roundup video, we'll review the most impactful environmental health and safety news.
Hi everyone! Welcome to the monthly news roundup video, where we’ll review the most impactful environmental health and safety news. Let’s take a look at what happened over the past month.
OSHA released an updated Job Safety and Health poster. Employers can use either the revised version or the older one, but the poster must be displayed in a conspicuous place where workers can easily see it.
OSHA recently removed a link from its Data topic webpage that displayed a list of “high-penalty cases” at or over $40,000 since 2015. The agency says it discontinued and removed it in December. The data is frozen and archived elsewhere.
OSHA published two new resources as part of its newly launched Safety Champions Program. The fact sheet provides an overview of how the program works, eligibility criteria, and key benefits. The step-by-step guide helps businesses navigate the core elements of OSHA’s Recommended Practices for Safety and Health Programs.
Several forces are nudging OSHA to address a number of workplace hazards and high-hazard industries. This comes from other agencies, safety organizations, watchdogs, legislative proposals, and persistent injury/fatality data. Among the hazards are combustible dust; first aid; personal protective equipment; and workplace violence. How all this translates into new regulations, guidance, programmed inspections, or other initiatives remains to be seen.
Turning to environmental news, EPA issued a proposed rule to require waste handlers to use electronic manifests to track all RCRA hazardous waste shipments. Stakeholders have until May 4 to comment on the proposal.
On March 10, EPA finalized stronger emission limits for new and existing large municipal waste combustors and made other changes to related standards.
And finally, EPA temporarily extended coverage under the 2021 Multi-Sector General Permit for industrial stormwater discharges until the agency issues a new general permit. The permit expired February 28 and remains in effect for facilities previously covered. EPA won’t take enforcement action against new facilities for unpermitted stormwater discharges if the facilities meet specific conditions.
Thanks for tuning in to the monthly news roundup. We’ll see you next month!
Most Recent Highlights In Human Resources
NewsCERCLA, SARA, EPCRA CERCLA, SARA, EPCRASafety and Health Programs and TrainingElectronic Reporting of Injury and Illness RecordsWater ProgramsMonthly Roundup VideoSafety and Health Programs and TrainingUSAWater ProgramsHazard CommunicationInjury and Illness RecordkeepingEnglishTier II Inventory ReportingIndustry NewsSafety & HealthInjury and Illness RecordkeepingWater ReportingGeneral Industry SafetyEnvironmentalHazard CommunicationSARA ComplianceFocus AreaVideo
EHS Monthly Round Up - January 2026
In this January 2026 roundup video, we'll review the most impactful environmental health and safety news.
Hi everyone! Welcome to the monthly news roundup video, where we’ll review the most impactful environmental health and safety news. Let’s take a look at what happened over the past month.
Chemical manufacturers, importers, distributors, and employers will have an extra four months to comply with the provisions of OSHA’s revised Hazard Communication standard. When the rule was revised in 2024, it contained staggered compliance dates for those who classify or use chemical substances and mixtures. The first compliance date is now May 19 rather than January 19 of 2026.
On January 8, OSHA issued further technical corrections to its Hazard Communication final rule. An initial set of corrections was published in October 2024, and OSHA continued to review the standard for errors. The agency said these corrections should reduce confusion during the chemical classification process and prevent errors on labels and safety data sheets.
In 2024, private industry employers reported 2.5 million nonfatal workplace injuries and illnesses, according to the Bureau of Labor Statistics. This is down 3.1 percent from 2023 and largely due to a decrease in respiratory illnesses. The greatest number of cases involving days away from work, job restriction, or transfer were caused by overexertion, repetitive motion, and bodily conditions, followed by contact incidents.
Registration is open for OSHA’s Safety Champions Program, which is designed to help employers develop and implement effective safety and health programs. Participants can work at their own pace through Introductory, Intermediate, and Advanced levels.
Turning to environmental news, on January 9, EPA withdrew its direct final rule on SDS/Tier II reporting tied to OSHA HazCom, before it had a chance to take effect. The direct final rule was published back on November 17, 2025, and was intended to relax the Tier II and safety data sheet reporting requirements and align with OSHA’s HazCom standard. EPA said it plans to write a new rule addressing all public comments.
And finally, EPA published a final rule that changes certain requirements for wastewater discharges from coal-fired steam electric power plants. It applies to the deadlines established by the preceding rule finalized in 2024.
Thanks for tuning in to the monthly news roundup. We’ll see you next month!
NewsIndustry NewsIndustry NewsToxic Substances Control Act - EPAToxic Subtances Control Act - EPATSCA ComplianceToxic Substances - EPAEnvironmental Protection Agency (EPA)EnvironmentalEnglishFocus AreaUSA
2026-05-07T05:00:00Z
EPA postpones compliance for TCE uses with TSCA Section 6(g) exemptions
On May 5, 2026, the Environmental Protection Agency (EPA) published a final rule postponing the effective date of compliance requirements for trichloroethylene (TCE) uses with Toxic Substances Control Act (TSCA) Section 6(g) exemptions until pending judicial review is concluded.
Who’s impacted?
The delay applies to the conditions imposed on each TSCA Section 6(g) exemption at 40 CFR 751.325, including the Workplace Chemical Protection Program requirements at 751.315.
Since the compliance requirements haven’t taken effect, facilities that use TCE with TSCA Section 6(g) exemptions don’t have to comply with the provisions yet.
Why the delay?
In December 2024, EPA released the final TCE rule (2024 TCE rule). The rule ultimately bans all uses of TCE, but it allows uses with TSCA Section 6(g) exemptions to continue for a limited time as long as facilities comply with strict workplace controls. Currently, the 2024 TCE rule is under judicial review. EPA has delayed the effective date of the requirements for TCE uses with TSCA Section 6(g) exemptions until the judicial challenges to the 2024 TCE rule are resolved.
If you have a sense of déjà vu, it’s for a good reason. This is the fifth time the agency has delayed the compliance requirements for TSCA Section 6(g) exemptions. However, EPA’s previous postponements established specific dates for the provisions to take effect, but this rule doesn’t.
Key to remember: EPA has delayed the compliance requirements for TCE uses with TSCA Section 6(g) exemptions until pending judicial review is concluded.
NewsSafe Drinking WaterChange NoticesChange NoticeWater ProgramsEnvironmentalCWA ComplianceEnglishWisconsinFocus Area
2026-05-04T05:00:00Z
Wisconsin adds requirements to federal lead and copper drinking water rule
Effective date: May 1, 2026
This applies to: Public water systems
Description of change: The Wisconsin Department of Natural Resources (department) finalized amendments to align state regulations with the Environmental Protection Agency’s (EPA’s) updated lead and copper control requirements for drinking water. While most of the amendments conform to federal standards, the state has additional standards. The department also:
- Requires community water systems to make four contact attempts (two more than federal requirements) by two different means for elementary schools and childcare facilities to schedule lead monitoring,
- Requires public water systems on reduced annual monitoring to analyze and report the same number of sample results for copper and lead (instead of the federal requirements that only half of the copper samples are analyzed),
- Requires public water systems undergoing temporary treatment or source water changes (unregulated by EPA) for more than 30 days to notify the department 10 days before the planned change or as soon as possible for an unplanned emergency change,
- Requires groundwater system water suppliers that request to limit their entry point sampling to obtain prior approval from the department,
- Requires water suppliers that provide point-of-use treatment devices for the corrosion control treatment compliance flexibility option to submit a written plan to the department (not required by the federal rule),
- Grants the department the authority to require analysis of total and dissolved lead during distribution system and site assessments where the federal rule doesn’t provide this authority to the state,
- Requires water suppliers that request to invalidate a reported sample result to provide substantial evidence that the sample meets one of the invalidation criteria in the rule, and
- Combines the lead and copper monitoring waivers into one waiver and requires public water systems to complete at least two 6-month rounds of standard tap water monitoring (for which the federal rule only requires one 6-month round).
NewsDistrict of ColumbiaChange NoticesChange NoticeCAA ComplianceEnvironmentalAir PermittingFocus AreaEnglishAir Programs
2026-05-04T05:00:00Z
District of Columbia updates odor control permit rules
Effective date: April 10, 2026
This applies to: Entities required to obtain an operating air permit under Nuisance Odor Regulations
Description of change: The District of Columbia’s Department of Energy and Environment (DOEE) finalized a rulemaking that allows sources of nuisance odors to implement odor controls before obtaining an operating air permit under 20 DCMR Section 200.
To qualify, an entity must obtain from the DOEE written approval of the controls in the Odor Control Plan (OCP) decision letter. Additionally, the source must apply for an operating permit under 200.2 within 60 days of receiving an OCP decision letter.
Related state info: Clean air operating permits state comparison
NewsChange NoticesChange NoticeCaliforniaMobile Emission SourcesCAA ComplianceEnvironmentalFocus AreaEnglishAir Programs
2026-05-04T05:00:00Z
California permanently adopts emergency vehicle rules
Effective date: April 1, 2026
This applies to: New vehicle and engine manufacturers
Description of change: The California Air Resources Board (CARB) permanently adopted the Emergency Vehicle Emissions Regulations, which CARB adopted in 2025 as a temporary measure.
The rule reverts the emission standards and requirements for vehicle and engine manufacturers to the regulations in effect before the adoption of:
- Advanced Clean Cars II (ACC II), and
- Heavy-Duty Engine and Vehicle Omnibus Low NOx (Omnibus).
CARB allows manufacturers to comply with ACC II and Omnibus requirements voluntarily.
In 2025, the Environmental Protection Agency revoked CARB’s waivers to implement the ACC II, Omnibus, and Advanced Clean Trucks rules.
New Network Poll
Most Popular Highlights In Environmental
NewsEnforcement and Audits - OSHAPesticidesWorker Protection from PesticidesIn-Depth ArticleHazard CommunicationHR ManagementEnglishUSAIndustry NewsOSHA InspectionsSafety & HealthContingent WorkforceConstruction SafetyGeneral Industry SafetyAgriculture SafetyMaritime SafetyEnvironmentalHazard CommunicationTemporary EmployeesFocus AreaPesticidesHuman Resources
2026-05-26T05:00:00Z
OSHA packs new HazCom directive with enforcement clues
The first compliance date for the amended Hazard Communication (HazCom) standard has arrived, and OSHA finally issued its updated directive. The CPL instructs OSHA officers on how to conduct inspections and issue citations under the standard. However, it also provides chemical manufacturers, importers, distributors, and employers with insight into what officers will be assessing.
In effect, this CPL translates regulatory text into inspector expectations. It shows what adherence to the standard looks like in practice. That makes it a critical resource given recent and upcoming dates at 29 CFR 1910.1200(j).
CPL rewritten for the 2024 standard
On May 19, 2026, OSHA posted a revised CPL 02-02-079, “Inspection Procedures for the Hazard Communication Standard (HCS 2024),” replacing the July 9, 2015, version. The 132-page document reflects the reconfigured HazCom standard published May 20, 2024, effective on July 19, 2024, along with corrections issued through early 2026.
The agency designed this enforcement playbook to maintain uniform inspections during the transition period and after full implementation. Because of the extensive regulatory changes to definitions, hazard classification, labeling, safety data sheets, and trade secrets, the CPL is not a light refresh.
For those familiar with the rulemaking, the new CPL edits will not be surprising. Still, the directive should provide more clarity than the regulatory text.
Front matter and appendices
Updates to Sections I to IX are typical of a CPL, including:
- Cancellation of the 2015 CPL;
- A modified title and references to the 2024 final rule and corrections;
- Alignment with revisions 7 and 8 of the United Nations Globally Harmonized System of Classification and Labelling of Chemicals (GHS); and
- A new summary of changes, historical background, and compliance dates.
OSHA also modernized appendices for dates, hazard lists, pictogram hazards, SDS review guidance, chemical resources, and related directives.
Reworked inspection guidelines
Section X outlines inspector instructions for paragraphs (b) through (j) of the standard. The latest modifications impact most sections:
- Scope, applicability, and exemptions — The directive offers new examples and expanded explanations, such as:
- A formaldehyde hazard example for hair smoothing products;
- An overview of pesticide labeling requirements and exemptions;
- Discussion of the EPA Agricultural Worker Protection standard preemption; and
- Greater detail about biological hazards from plants.
- Definitions — The document introduces terms and explains bulk shipment, immediate outer package, physical hazard, released for shipment, and more. It also revisits the terms combustible dust and manufacturer. Lithium-ion batteries are now referenced in the distributor context.
- Hazard classification — The directive instructs OSHA officers to consider the classification of:
- Hazards associated with a chemical’s intrinsic properties, including changes in physical form and reactions from known or reasonably anticipated uses; and
- Impurities, additives, and individual constituents.
- Written plan — The directive clarifies:
- Employers must revise programs by the compliance dates when new information is received from suppliers;
- The use of computers and third-party administrators of safety data sheets (SDSs); and
- The written program must describe how employees will be trained in a language and at a literacy level they understand.
- Labeling — The directive broadens the sections on Department of Transportation labeling, bulk shipments, and small container labeling. It incorporates final rule flexibility too:
- Phased-in compliance dates for labeling;
- Hazards not otherwise classified (HNOCs) and hazards identified and classified under 1910.1200(d)(1)(ii) don’t need to be addressed on the container;
- The exclamation mark pictogram is permitted (but not required) for HNOCs, under certain conditions;
- Minor textual variations for precautionary statements are allowed; and
- OSHA offers alternatives for chemical containers released for shipment.
- Safety data sheets (SDSs) — Amended text focuses on U.S. jurisdiction and technical provisions, such as:
- Phased-in compliance dates for SDSs;
- Importer SDS responsibilities;
- Using a U.S. address and phone number;
- The hazard class and category reflecting intrinsic properties;
- Required Chemical Abstracts Service (CAS) number or other unique identifiers; and
- No need to obtain updated SDSs to replace already received SDSs.
- Employee information/training — The directive references a temporary workers bulletin. It also emphasizes:
- Phased-in compliance dates for necessary training adjustments; and
- Delivering training in a language employees understand.
- Trade secrets — The instruction aligns with the 2024 rule:
- Allows the exact percentage, exact concentration range, or CAS number to be withheld if certain criteria are met; and
- Addresses the use of confidentiality agreements.
- Dates — The directive overhauls compliance timelines and discusses documentation of due diligence and good faith efforts.
In addition, the directive softens citation language with phrases like “should normally cite” instead of “shall cite.” This shift suggests inspectors may have greater discretion based on case-specific circumstances.
Key to remember
While 1910.1200 remains the baseline for employers and chemical manufacturers, importers, and distributors, the revised CPL 02-02-079 provides an enforcement lens. With implementation underway, regulated entities can use the CPL to steer their efforts and conform with how OSHA will inspect them in the field.
NewsIndustry NewsSafety & HealthGeneral Industry SafetyIndoor Air QualityIndustrial HygieneCAA ComplianceEnvironmentalIn-Depth ArticleEnglishFocus AreaUSA
2026-05-22T05:00:00Z
Where workplace exposure meets air permitting: Bridging OSHA industrial hygiene and EPA air programs
Air quality inside a facility and emissions leaving a stack are closely linked. The same chemicals that drive occupational exposure limits under the Occupational Safety and Health Administration (OSHA) often form the basis of regulated air pollutants under the Environmental Protection Agency's (EPA's) programs.
When industrial hygiene (IH) and environmental compliance teams work together, they can spot risks sooner, strengthen controls, and avoid surprises in permits or inspections. The overlap is practical. Worker exposure data can inform stack testing, and permit conditions can signal where IH monitoring should focus.
Shared chemistry, different lenses
Both programs start with the same substances, such as solvents, metals, acids, and combustion byproducts. IH focuses on what workers breathe in the workplace. It uses exposure limits such as OSHA permissible exposure limits or more protective guidelines from the National Institute for Occupational Safety and Health (NIOSH) and the American Conference of Governmental Industrial Hygienists (ACGIH). Environmental air programs focus on what leaves the property. They regulate criteria pollutants, hazardous air pollutants (HAPs), and toxics using emission limits, control requirements, and reporting rules.
The data tools look similar. IH uses personal and area sampling, direct-reading instruments, and task-based assessments. Environmental programs use emission factors, mass balance, continuous monitoring, and periodic stack testing. Both require documentation, quality control, and records.
Key differences that matter
The point of exposure is the biggest difference. IH evaluates the breathing zone of a worker during a task or shift. Environmental programs measure emissions at a release point, such as a stack, or estimate them across the site.
The time frame also differs. IH often looks at short-term peaks and full-shift averages to protect health during work. Air permits may set hourly, daily, or annual limits, and they may cap total emissions per year. Control strategies follow these goals. IH may rely on local exhaust ventilation, enclosure, or work practice changes. Air permits may require add-on controls such as thermal oxidizers, scrubbers, or filters.
Practical crossover: Using IH to inform permitting
IH data can reveal which tasks generate the highest concentrations and which compounds dominate exposure. That insight can refine emission estimates. For example, if wipe cleaning with a solvent produces the highest worker exposure, the same solvent may drive facility-wide volatile organic compound (VOC) emissions. The environmental team can use that knowledge to prioritize accurate emission factors, refine mass balance, or plan stack testing during peak operations.
IH data also helps define realistic operating scenarios for compliance testing. Stack tests that occur only at typical loads may miss worst-case conditions. Pairing test timing with identified peak tasks can provide a more representative test and reduce the risk of later noncompliance.
Practical crossover: Using permits to inform IH
Air permits define regulated compounds, control devices, and operating limits. These details can guide IH planning. If a permit lists specific HAPs or requires a control device for a process, there's a clear signal that exposure to those compounds is possible near the source. IH can target those areas for baseline sampling, validate control performance, and confirm that capture systems are effective where workers are present.
Permit conditions also flag upset and startup modes. These periods can increase emissions. IH can align monitoring during these windows to assess short-term exposures and ensure that work practices and protective measures are adequate.
Aligning controls for dual benefit
Engineering controls can serve both goals when designed as a system. Capture at the source reduces worker exposure and lowers emissions to the stack. Good enclosure and balanced ventilation improve control efficiency and reduce fugitive releases. Preventive maintenance on control devices supports permit limits and keeps workplace air clean.
Administrative controls can align as well. Standard operating procedures can link production rates, control device settings, and ventilation checks. Change management should include both an IH review and an air permitting check to see if a modification triggers a permit update.
Communication and workflows
Successful crossover depends on routine communication. Regular meetings enable safety and environmental staff to share results, plan sampling, and coordinate testing windows. Shared inventories of chemicals and processes reduce duplication and errors. A common data platform, or at least a consistent file structure, makes it easier to compare IH results with emission estimates and permit limits.
Clear triggers help teams act. Examples include a new chemical introduction, a process change, a spike in IH results, or a deviation in control device performance. Each trigger should prompt both an IH review and an environmental compliance check.
Key to remember: When teams connect their data and plans, they gain a clearer picture of risk. The results are stronger compliance, better worker protection, and more efficient operations.
NewsIndustry NewsIndustry NewsToxic Substances Control Act - EPAToxic Subtances Control Act - EPATSCA ComplianceToxic Substances - EPAEnvironmental Protection Agency (EPA)EnvironmentalEnglishFocus AreaUSA
2025-08-15T05:00:00Z
EPA releases July 2025 TSCA Inventory
On August 14, 2025, the Environmental Protection Agency (EPA) released the biannual update to the nonconfidential Toxic Substances Control Act (TSCA) Chemical Substance Inventory (TSCA Inventory). The inventory includes all TSCA-regulated chemical substances manufactured, processed, or imported in the U.S.
The July 2025 TSCA Inventory contains 86,862 chemicals, adding 15 chemical substances since the last update. Nearly half of the substances (42,578) are active (i.e., in use). EPA also updated:
- Commercial activity data,
- Unique identifier data, and
- Regulatory flags (which identify substances with manufacturing or use restrictions as well as substances with full or partial reporting exemptions).
Further, the agency updated the TSCA Master Inventory File. It includes chemical identity information claimed as confidential that’s excluded from the nonconfidential TSCA Inventory. The TSCA Master Inventory File is the only list with comprehensive, authoritative information about which chemical substances are on the inventory.
The agency plans to make the next inventory update in Winter 2026.
How do I access the inventory?
View the TSCA Inventory by:
- Downloading the Microsoft Access or CSV text version of the data from EPA’s website, or
- Using EPA’s Substance Registry Services (SRS).
How does this impact my business?
The TSCA Inventory helps facilities determine compliance requirements for chemicals they (a) manufacture or use or (b) plan to manufacture or use. Chemicals that are on the TSCA Inventory are likely subject to rules, like manufacturing limits and reporting requirements. Chemicals that aren’t on the list must meet notification and review requirements before they can be used.
Key to remember: EPA released the July 2025 nonconfidential TSCA Inventory of chemical substances manufactured, processed, or imported in the U.S.
NewsWater ProgramsEnvironmental Protection Agency (EPA)Mobile Emission SourcesCAA ComplianceAir PermittingWater ProgramsCWA ComplianceEnglishAir ProgramsIndustry NewsIndustry NewsWater PermittingPoint SourcesCriteria Air PollutantsIndustrial WastewaterEnvironmentalFocus AreaAir ProgramsStationary Emission SourcesUSA
2026-05-19T05:00:00Z
EPA proposes major changes to multiple rules
The Environmental Protection Agency (EPA) has been on a rulemaking roll! In recent weeks, the agency has published significant proposed rules in the Federal Register that affect coal-fired power plant wastewater, pre-construction air permits, and vehicle emission requirements.
Coal-fired power plants: Unmanaged CRL discharges
EPA proposes to revise the wastewater requirements established by a 2024 final rule (2024 Rule) for unmanaged combustion residual leachate (CRL) from coal-fired power plants.
Unmanaged CRL (a type of waste stream) is water that contains coal combustion residuals and leaks from landfills or surface impoundments (i.e., waste management units). Unmanaged CRL includes:
- Pumped unmanaged CRL (leached CRL that’s captured, pumped to the surface, and discharged directly to waters of the United States); and
- The functional equivalent of an unmanaged CRL direct discharge (determined by the permitting authority).
The proposed rule applies to coal-fired power plants with unmanaged CRL that are subject to the 2024 Rule’s technology-based effluent limitations guidelines and standards.
The agency proposes three options to revise the unmanaged CRL requirements:
- Option 1 (preferred by EPA) would maintain the 2024 rule’s mercury and arsenic numeric limits for pumped unmanaged CRL discharges, but it would delay the compliance deadline from December 31, 2029, to December 31, 2034. Additionally, the permitting authorities would determine best available technology economically achievable (BAT) limits for functional equivalents on a case-by-case basis.
- Option 2 would maintain the 2024 rule’s mercury and arsenic numeric limits for pumped unmanaged CRL discharges and functional equivalents. It would also maintain the original compliance timeline of December 31, 2029.
- Option 3 would impose zero-discharge limits for all pollutants in pumped unmanaged CRL discharges and functional equivalents. It would also establish interim BAT limits for mercury and arsenic. Facilities would have to meet the zero-discharge limits by December 31, 2034.
Public comments are due by June 17, 2026 (Docket ID No. EPA–HQ–OW–2009–0819).
Pre-construction air permits: Begin actual construction
EPA proposes to allow construction-related activities on components or structures that don’t emit air pollutants to start before obtaining a New Source Review (NSR) pre-construction permit to build or modify a stationary source. The proposed rule:
- Redefines “begin actual construction," and
- Adds “pollutant-emitting activities” to the regulatory definitions.
Both definitions list equipment, components, and processes that are excluded, meaning that construction on these activities may begin before obtaining an NSR permit. Examples of exempt activities include compacting and stabilizing soil, paving surfaces, and installing concrete pads.
If finalized, the proposed rule will distinguish between construction on stationary sources and construction on non-emitting components (e.g., utility infrastructure, certain building foundations) and codify that on-site construction of non-emitting components or structures can begin before getting an NSR permit.
Public comments are due by June 29, 2026 (Docket ID No. EPA-HQ-OAR-2025-0618).
Light- and medium-duty vehicle regulations: Tier 4 standards
EPA published Part 1 of a two-part rulemaking effort to revise the Tier 4 criteria air pollutant standards set in 2024 (Tier 4 Rule) for light- and medium-duty vehicles (LMDVs), which include:
- Light-duty vehicles and trucks,
- Medium-duty passenger vehicles, and
- Medium-duty vehicles.
In Part 1, EPA proposes to amend the phase-in schedule for Tier 4 criteria air pollutant requirements by:
- Extending the Tier 3 standards set in 2014 (Tier 3 Rule) for LMDVs to model years (MYs) 2027 and 2028,
- Delaying the start of phasing in Tier 4 standards for LMDVs from MY 2027 to MY 2029, and
- Removing the optional early phase-in of Tier 4 standards for LMDVs with a gross vehicle weight rating of more than 6,000 pounds from MYs 2027 and 2028.
The agency also proposes to delay changes to the test protocols for emissions performance certification evaluations to MY 2029.
In Part 2, EPA will reconsider the Tier 4 Rule for LMDVs, which may include changing emission standards, lead time and phase-in schedules, and test procedures.
Public comments are due by July 6, 2026 (Docket ID No. EPA–HQ–OAR–2025–3297).
Key to remember: EPA has issued a series of proposed rules that, if finalized, may have significant regulatory impacts on power plant wastewater, pre-construction air permits, and vehicle emission requirements.
NewsGreenhouse GasesWaste/HazWasteToxic Substances Control Act - EPASafe Drinking WaterWater AnalysisWater ProgramsWater QualityMaximum Contaminant LevelsWalking Working SurfacesMonthly Roundup VideoCAA ComplianceSolid WasteCWA ComplianceLaddersEnglishUSAHeat StressIndustry NewsHeat and Cold ExposureSafety & HealthGeneral Industry SafetyWasteMaritime SafetyEnvironmentalFocus AreaWater MonitoringVolatile Organic CompoundsAir ProgramsStationary Emission SourcesVideo
EHS Monthly Round Up - April 2026
In this April 2026 roundup video, we’ll review the most impactful environmental health and safety news.
Hi everyone! Welcome to the monthly news roundup video, where we’ll review the most impactful environmental health and safety news. Let’s take a look at what happened over the past month.
OSHA revised its National Emphasis Program on heat-related hazards. Going forward, the agency will prioritize inspections in 55 high-risk industries in indoor and outdoor work settings. The program remains in effect for 5 years from its April 10 effective date.
An OSHA proposed rule seeks to eliminate the November 18, 2036, deadline in the Walking-Working Surfaces standard that would require all fixed ladders extending more than 24 feet above a lower level to be equipped with personal fall arrest systems or ladder safety systems. OSHA also seeks feedback on nine specific questions related to the proposal, with comments due on June 5.
On April 17, OSHA revoked its House Falls in Marine Terminals standard at 1917.41. The agency said that because most cargo has been containerized and is moved by cranes, the standard is no longer necessary to protect employees.
Turning to environmental news, an EPA final rule further delays the submission period for the one-time PFAS report required of manufacturers. It pushes the start of the submission period to either 60 days after the effective date of a future final rule updating the PFAS Reporting Rule or January 31, 2027, whichever comes first.
An EPA final rule makes technical changes to the emission standards established in March 2024 for crude oil and natural gas facilities. The changes take effect June 8.
EPA published the draft 6th Contaminant Candidate List for the next group of contaminants to be considered for regulation under the Safe Drinking Water Act. The proposed list designates microplastics and pharmaceuticals as priority contaminant groups for the first time.
And finally, EPA plans to make significant changes to coal combustion residuals requirements. A proposed rule published April 13 would revise the regulations governing the disposal of coal combustion residuals in landfills and surface impoundments, as well as the beneficial use of coal combustion residuals.
Thanks for tuning in to the monthly news roundup. We’ll see you next month!
NewsIndustry NewsTSCA ComplianceCAA ComplianceSustainabilityIn-Depth ArticleCWA ComplianceEnvironmentalEnglishSustainabilityESG (Environmental, Social, and Governance)Focus AreaUSA
2025-12-05T06:00:00Z
EPA’s 2026 regulatory shift: How environmental managers can stay ahead
The clock is ticking for environmental teams. By 2026, several new EPA regulations will reshape compliance obligations for U.S. companies. Organizations that act now will avoid costly penalties and operational disruptions.
What’s changing and why it matters
Although EPA has been deregulating or loosening some requirements, there are still some standards being tightened across multiple fronts in the coming year:
- Renewable fuel standards (RFS): The EPA proposed higher volume requirements for 2026, including 24.02 billion renewable identification numbers (RINs), up nearly 8% from 2025. This increase pushes stricter expectations on fuel producers and organizations purchasing renewable fuels.
- Stormwater multi-sector general permit (MSGP): A new MSGP set to take effect by February 2026 will require quarterly PFAS indicator monitoring, expanded benchmark sampling, and resiliency measures in stormwater control designs.
- PFAS Reporting under the Toxic Substances Control Act (TSCA): TSCA Section 8(a)(7) mandates PFAS manufacturing and import data collection beginning in April 2026, through October 2026, with extended deadlines for certain small manufacturers.
Failure to prepare could lead to fines, reputational damage, supply chain disruptions, and permit delays. Companies that weave compliance planning into their 2026 strategy will be positioned not just to meet legal deadlines but to sustain operations smoothly.
Key areas of impact
- Renewable fuel standards (RFS) and air emissions The proposed increase in 2026 Renewable Identification Numbers (RIN) volumes, from 24.02 billion to 24.46 billion for 2027, signals tightening air and fuels policy that affects fuel use and emissions accounting.
- Stormwater management The upcoming 2026 MSGP requires expanded quarterly PFAS monitoring, new benchmark triggers, corrective action plans, and integration of climate resilience in design standards.
- PFAS disclosure (TSCA Section 8(a)(7)) Manufacturers and importers of PFAS must submit electronic reporting of usage, volumes, disposal, and exposure data between April and October 2026, with extensions available for smaller operations.
Steps to take now
- Audit compliance programs: Cross-check operations against RIN inventory, stormwater permits, and TSCA reporting duties.
- Upgrade monitoring and recordkeeping: Implement robust electronic systems to track PFAS, stormwater quality, fuel volumes, and emissions.
- Staff training: Educate teams on PFAS obligations, new stormwater protocols, and RFS structures.
- Engage regulators early: Comment on proposed rules, consult during permit drafting, and flag issues during the notice-and-comment period.
Looking ahead
The EPA’s 2026 updates reflect a trend toward increased transparency and environmental accountability. Companies that treat compliance as strategic will not only avoid enforcement but also gain resilience and stakeholder trust.
Key to remember: Start planning now. Early action on EPA rule changes will save time, money, and headaches when enforcement begins.
Most Popular Highlights In Transportation
NewsIndustry NewsFleet SafetyTrainingTrainingTraining & DevelopmentFocus AreaIn-Depth ArticleUSAEnglishTransportationHuman Resources
2026-05-26T05:00:00Z
From orientation to on-road excellence: Build a training program that delivers results
Effective driver training programs are not built on ride-alongs alone. They are built on structure, consistency, and measurable outcomes. Carriers that develop a formal, written approach to training create a program that is repeatable, defensible in an audit, and capable of producing safe, professional drivers over time. Here’s how they do it.
Start with written policies that define the trainers’ roles and goals
Every trainer should operate from a clear policy that outlines expectations. This includes the trainer’s responsibility to model compliant behavior, document progress, and coach drivers. Goals should be specific and measurable, such as ensuring learners demonstrate proficiency in pre-trip inspections, hours-of-service (HOS) compliance, backing maneuvers, and defensive driving techniques. When trainer expectations are written and standardized, the carrier reduces inconsistency and ensures every learner receives the same level of instruction.
Build written program guidelines that define how training is delivered
A strong program includes documented procedures for each phase of training. This should cover classroom instruction, yard skills, and on-road driving. Guidelines should define required skills demonstrations, and the sequence in which training occurs. They should also clearly distinguish between observation, supervised practice, and independent performance. This structure ensures that training is not rushed and that drivers build skills progressively rather than being pushed through to fill seats.
Establish clear written criteria for driver certification
Certification should not be based on time alone. It should require demonstrated competency. Written guidelines should define what a driver must do to be released, such as completing a compliant pre-trip inspection without assistance, maintaining lane control and proper following distance, executing safe backing maneuvers, and adhering to company policies. Documentation should support each certification decision, creating a record that the driver met objective standards.
Adapt training as hiring criteria evolve
As hiring standards shift, training must be adjusted accordingly. Less experienced drivers require more foundational instruction, longer training periods, and greater emphasis on basic vehicle control and compliance habits. Experienced hires may need shorter programs focused on company-specific policies and correcting bad habits. A training program will fail if it does not reflect the actual skill level of incoming drivers.
Measure results beyond program completion
Completing training does not equal success. Carriers need a system to evaluate whether training is effective in the real world. This includes tracking key performance indicators such as preventable accidents, roadside inspection violations, HOS compliance errors, and telematics data (speeding, hard braking, lane control). These metrics should be tied back to individual drivers and training to identify trends.
Define what “good” looks like and measure behavior in the field
Drivers need clear expectations. Define “good” in observable terms such as consistent mirror usage, proper following distance, smooth braking, accurate log entries, and thorough inspections. Follow-alongs or ride-alongs can then be used to verify these behaviors in real operating conditions. These evaluations should be structured with scorecards or checklists to ensure consistency and provide objective feedback.
Continuously improve trainers and the program itself
Trainer development is just as important as driver development. Trainer certifications should be reviewed and updated regularly, ensuring trainers stay current on regulations, company policies, and coaching techniques. Additionally, data gathered from driver performance should be fed back into the training program. If certain violations or risky behaviors appear repeatedly, the program should be updated to address those gaps directly.
Key to remember: With written standards, measurable outcomes, and continuous improvement, carriers can move beyond basic compliance and build a program that truly reduces risk and develops professional drivers.
NewsIndustry NewsFleet SafetyRisk Management TransportationRisk Management - Motor CarrierFocus AreaIn-Depth ArticleFleet OperationsEnglishTransportationUSA
2026-05-28T05:00:00Z
5 keys to being a defendable motor carrier
Becoming a defendable motor carrier requires disciplined execution in a few critical areas:
- Accident response,
- Documentation,
- Driver performance management, and
- Compliance.
The goal is simple—reduce risk and clearly demonstrate that your company takes safety seriously. This starts with the top leadership in the organization.
1. Create a strong accident response and investigation
The first step after a crash is getting the right information — fast. After a crash, safety comes first, followed immediately by collecting accurate, unbiased data. Engage legal counsel immediately if the crash severity indicates potential litigation.
Capture photos, vehicle positions, roadway conditions, and witness statements while details are fresh. Preserve electronic data like dash cam footage, electronic logging device (ELD) records, and telematics immediately.
Also, ensure someone qualified gathers scene data—whether that’s the driver, a safety employee, or preferably an insurance adjuster or accident reconstructionist. Without timely evidence, later investigation becomes guesswork.
2. Build a complete evidence file
A defendable carrier backs up its position with documentation. Also, examining all evidence provides a complete picture of potential liability, even if the facts show carrier or driver actions or inaction contributed to the crash.
After the crash, gather:
- Police and inspection reports,
- Dash cam footage from the carrier’s vehicle and other vehicles,
- Traffic or other structure camera footage,
- Driver logs and communication records,
- Maintenance and inspection records,
- Electronic control module data, and
- DOT drug/alcohol test results.
Just as important as collecting the data is protecting it. Maintain secure storage and a clear chain of custody to avoid questions about data integrity. As appropriate, place items like a driver’s cell phone under attorney-client privilege.
3. Focus on avoiding crashes and unsafe or illegal behavior
As an ongoing part of the safety program, reduce unsafe or illegal driver behavior through proactive coaching, retraining, or discipline. At the same time, evaluate company policies, procedures, and operational pressures that may contribute to crashes or unsafe behavior. Make appropriate adjustments to enhance safety management controls.
Consistency in following a progressive discipline and training policies is critical. If a policy says a violation leads to termination, failing to follow through can create major retention risk. Document decisions and follow the established processes. Exceptions to policies weakens a carrier’s defense.
Use data from dash cams and telematics to identify high-risk behaviors like speeding, distraction/cell phone use, lack of seat belt use, or following too closely. Focus coaching on illegal behavior or those most likely to result in crashes or injuries.
Equally important—balance correction with recognition. Reinforcing positive behavior builds driver buy-in and strengthens a carrier's safety culture.
4. Establish clear policies and enforce them
Policies are where you define expectations and prove your commitment to safety.
Strong policies should:
- Define acceptable and unacceptable behaviors,
- Outline training and corrective action processes,
- Ensure consistent enforcement with minimal exceptions, and
- Address privacy and data use (especially with cameras).
Regularly review, update, and document all policy changes and training.
5. Ensure leadership support
A defendable carrier starts with the top leadership who must prioritize safety over productivity and support it with resources, technology, and accountability.
Every department’s leadership—not just the safety director—must share responsibility for safe operations.
Keys to remember: A defendable carrier isn’t defined by whether accidents happen, but by how the company prepares, responds, and improves. Strong processes to collect evidence and demonstrate consistent actions to avoid crashes make all the difference.
NewsIndustry NewsHazmat PlacardingHazmat SafetyExpert InsightsFocus AreaHazmat markings, Placards, and LabelsEnglishTransportationUSA
2026-05-22T05:00:00Z
Expert Insights: Common hazmat placarding mistakes
Placards are one of the most visible parts of hazmat compliance. Anyone on the road can see them, including drivers, enforcement officials, and emergency responders. Because of that visibility, most people I talk to assume that placarding is simple. In reality, it’s one of the areas where small oversights show up fast and can create major compliance issues.
In my experience, most violations don’t come from a lack of effort. They usually come from assumptions, habits, or misunderstandings about how the rules apply in real-world operations. When I take a closer look at placarding issues, the same patterns tend to show up. Once you start recognizing those patterns, it becomes a lot easier to catch issues early and avoid problems during inspections or incidents.
Using the wrong placard or using it at the wrong time
One of the most common mistakes I see is using a placard that doesn’t match the material being transported. This usually happens when someone relies on memory instead of verifying the hazard class, or when subsidiary risks get overlooked. Even experienced employees fall into this habit when things start moving too fast.
I also see situations where the placard is technically correct but used at the wrong time. A placard might be left on from a previous load or put on in anticipation of a future shipment. Placards aren’t general warnings. They need to reflect exactly what’s in the vehicle at that moment.
Failing to remove placards
Another issue I run into a lot is failing to remove placards when the hazard is no longer present. This tends to happen when equipment is reused frequently or when operations are trying to keep things moving. It may seem like a small detail, but it creates real risk.
If a placard is displayed, responders are going to assume the hazard is there. That can impact how they respond in an emergency and lead to unnecessary precautions. From a compliance perspective, displaying a placard that doesn’t match the contents of the vehicle is a violation and usually draws unwanted attention during inspections.
Misunderstanding when placards are required
Placarding decisions aren’t always straightforward, especially when packaging types and quantities vary. I usually see teams assume that placards are always required any time hazmat is present. That approach can lead to over-placarding and send the wrong message.
On the other side, I also see required placards get missed because quantities aren’t evaluated correctly. Smaller packages can still trigger placarding when they’re combined. Taking a few extra minutes to verify packaging type and total quantity can make all the difference.
Placement and visibility issues
Even when the right placards are selected, they’re not always displayed properly. Placards need to be clearly visible and in good condition, but this is something I see get overlooked in day-to-day operations. Dirt, damage, and equipment can all block or reduce visibility.
If a placard can’t be easily seen, it’s not doing its job. I always recommend building placement and condition checks into routine inspections, not just focusing on whether the correct placard was chosen. This becomes even more important in environments where equipment sees heavy use.
What this means in the real world
When I look at placarding overall, I don’t see it as just a basic requirement. It’s a real-time communication tool that people rely on to make decisions. Every incorrect, missing, or unnecessary placard sends the wrong message and increases risk.
The good news is that most of these mistakes are preventable. Clear procedures, consistent training, and routine checks go a long way. When teams start treating placarding as an active part of hazard communication instead of just another requirement, I see better decisions and fewer mistakes.
NewsIndustry NewsIn-Depth ArticleExempt Carrier AuthorityFocus AreaOperating AuthorityFleet OperationsEnglishTransportationUSA
2022-08-31T05:00:00Z
What are exempt for-hire carriers exempt from?
With carriers looking for additional revenue streams, many otherwise private and new carriers wonder whether they can become “exempt” for-hire carriers.
The “exempt for hire” designation is for property carriers that carry certain “exempt commodities,” but do so for compensation. The designation is a holdover from the Interstate Commerce Commission (ICC). Most of the commodities are minimally processed agriculture items, but there’s a fair number of surprises – both in what’s included and what’s not.
The Federal Motor Carrier Safety Administration (FMCSA) provides a relatively short list of items that are not exempt in 49 CFR 372.115. The agency provides a much more robust list of both exempt and non-exempt commodities in Administrative Rule 119.
Exempt carriers are not required to have a motor carrier or MC number designating for-hire authority. However, exempt carriers are required to have a USDOT number. In order to maintain an exempt for-hire status, the carrier must never haul a commodity that is not exempt for compensation.
Do exempt carriers need to have proof of insurance?
Carriers that haul exempt commodities are required to have the minimum level of financial responsibility required by 49 CFR 387, and their insurance provider must provide the carrier with an MCS-90 endorsement. However, the insurance need not be on file with the FMCSA. Many states have insurance requirements both for the amount required and the need to carry proof of coverage in the vehicle. Federally exempt for-hire carriers are not exempted from any state requirement.
Are exempt for-hire carriers required to name process agents?
Currently, exempt-for hire carriers are not required to name process agents for each state of operation as other for-hire carriers are required to do so on the BOC-3 form. That may change when the FMCSA fully implements their Unified Registration System, or URS. The system was introduced with a final rule in the summer of 2013 and included a provision requiring exempt carriers to have process agents. Much of the rule was suspended at the beginning of 2017. At some point, the agency would like to get the URS ball rolling again.
Are exempt carriers exempt from IFTA, IRP, HVUT, and UCR?
Exempt for-hire carriers are not exempt from the alphabet soup of revenue generating programs of the International Fuel Tax Agreement (IFTA) allowing for the sharing of fuel tax revenue, the International Registration Plan (IRP) allowing for the sharing of vehicle registration fees, the Internal Revenue Service’s (IRS) tax for heavy vehicles that weight 55,000 pounds or more, or for the Unified Carrier Registration (UCR) revenue generating program.
Are exempt carriers exempt from the Federal Motor Carrier Safety Regulations (FMCSRs)?
Exempt carriers are not automatically exempt from the safety regulations such as driver qualifications, drug and alcohol testing, commercial driver licenses, vehicle inspections, or the hours-of-service rules. Although livestock and agriculture commodity carriers may qualify for the hours-of-service agriculture exemption.
Key to remember: “Exempt” commodity haulers are exempt from very little. Primarily they are exempt from needing for-hire authority and designating process agents.
NewsEnglishFleet SafetyChange NoticesChange NoticeDrug and Alcohol Testing - DOTDrug testing - Motor CarrierOffice of the Secretary of TransportationFocus AreaAlcohol testing - Motor CarrierTransportationUSA
2026-05-11T05:00:00Z
DOT Final Rule: Procedures for Transportation Workplace Drug and Alcohol Testing Programs
The U.S. Department of Transportation revises its drug and alcohol testing procedures to require a directly observed urine collection in situations where oral fluid tests are currently required but cannot be conducted because oral fluid testing is not yet available. The rule also updates terminology in these procedures consistent with Executive Order (E.O.) 14168, Defending Women from Gender Ideology Extremism and Restoring Biological Truth to the Federal Government.
DATES: This rule is effective on June 10, 2026. Published in the Federal Register May 11, 2026, page 25507.
View final rule.
| §40.65 What does the collector check for when the employee presents a urine specimen? | ||
| (d) | Added | View text |
| §40.67 When and how is a directly observed urine collection conducted? | ||
| (g) | Revised | View text |
| (h) | Revised | View text |
| §40.69 How is a monitored urine collection conducted? | ||
| (c) | Revised | View text |
| (d) | Revised | View text |
| §40.145 [Amended] | ||
| (h)(1)(ii) | Revised | View text |
Previous text
§40.67 When and how is a directly observed urine collection conducted?
* * * *
(g) As the collector, you must ensure that the observer is the same gender as the employee.
(1) You must never permit an opposite gender person to act as the observer.
(2) The observer can be a different person from the collector and need not be a qualified collector.
(3) If a same gender collector cannot be found or in circumstances of nonbinary or transgender employees:
(i) If the employer has a standing order to allow oral fluid testing in such situations, the collector will follow that order;
(ii) If there is no standing order from the employer, the collector must contact the DER and either conduct an oral fluid test if the collection site is able to do so, or send the employee to a collection site acceptable to the employer for the oral fluid test.
(h) As the collector, if someone else is to observe the collection (e.g., in order to ensure a same gender observer), you must verbally instruct that person to follow procedures at paragraphs (i) and (j) of this section. If you, the collector, are the observer, you too must follow these procedures.
§40.69 How is a monitored urine collection conducted?
* * * *
(c) As the collector, you must ensure that the monitor is the same gender as the employee, unless the monitor is a medical professional (e.g., nurse, doctor, physician’s assistant, technologist, or technician licensed or certified to practice in the jurisdiction in which the collection takes place). The monitor can be a different person from the collector and need not be a qualified collector.
(d) As the collector, if someone else is to monitor the collection (e.g., in order to ensure a same gender monitor), you must verbally instruct that person to follow the procedures of paragraphs (d) and (e) of this section. If you, the collector, are the monitor, you must follow these procedures.
§40.145 On what basis does the MRO verify test results involving adulteration or substitution?
* * * *
(h)(1)(ii) Assertion by the employee that his or her personal characteristics (e.g., with respect to race, gender, weight, diet, working conditions) are responsible for the substituted result does not, in itself, constitute a legitimate medical explanation. To make a case that there is a legitimate medical explanation, the employee must present evidence showing that the cited personal characteristics actually result in the physiological production of urine meeting the creatinine and specific gravity criteria of §40.88(b).
NewsIndustry NewsFleet SafetyPassenger vehiclesPassenger carriersFocus AreaIn-Depth ArticleFleet OperationsEnglishTransportationUSA
2025-08-12T05:00:00Z
Is your shuttle bus legal? 5 key questions that need answers
Smaller passenger-carrying vehicles—like hotel, car rental, senior living facility, and employee shuttles—may be commercial motor vehicles (CMVs) subject to the Federal Motor Carrier Safety Regulations (FMCSRs). Knowing which rules apply can help you avoid fines, reduce litigation risks, and lower insurance costs.
5 key questions to determine applicability
To find out if the FMCSRs apply to your shuttle vehicle(s), answer these five questions:
1. Is your operation interstate or intrastate?
- Interstate commerce includes any travel that crosses state lines or is part of a trip that begins or ends out of state—even if the vehicle stays within one state. Shuttles picking up passengers from or delivering them to an airport is an example of a continuation of interstate commerce.
- Intrastate commerce is travel that stays entirely within one state and is not part of an interstate journey.
2. How many passengers is the vehicle designed to carry?
- The FMCSRs apply to vehicles designed to carry 9 to 15 passengers (including the driver) if used for compensation.
- If rated for more than 15 passengers (including the driver), the vehicle is a CMV regardless of compensation.
- Removing some of the seats doesn't change the vehicle’s regulatory classification.
3. What is the vehicle’s weight?
- Regulations apply if the gross vehicle weight rating (GVWR) or actual loaded weight is 10,001 pounds or more, regardless of compensation.
- Example: An employee shuttle, even if there is no compensation received from passengers, is a CMV if the weight exceeds 10,000 pounds.
4. Is the operation for-hire or private?
- For-hire carriers that operate CMVs to transport passengers for compensation and are subject to the FMCSRs.
- Private motor carriers of passengers (PMCPs) may also be regulated:
- Business PMCPs (e.g., employee shuttles) follow most FMCSRs, but are exempt from insurance rules.
- Non-business PMCPs (e.g., church groups) must operate safely, but are exempt from many FMCSRs, including:
1. Insurance,
2. Driver qualification requirements listed under 391.68,
3. Hours-of-service (HOS) logs (but must comply with HOS limits),
4. Maintenance records as required by 396.3(b), and
5. Driver vehicle inspection reports (DVIRs).
5. What kind of compensation is received?
- Direct compensation: Payment from passengers for transportation (e.g., ticket sales).
- Indirect compensation: Transportation included in a broader service (e.g., hotel or tour packages).
- If no compensation is received, the vehicle is rated for 15 or fewer passengers including the driver, and the vehicle is under 10,001 pounds, the FMCSRs generally don't apply.
General compliance requirements based on compensation for 9–15 passenger-carrying vehicles are as follows:
- Direct compensation or 10,001 pounds or greater:
- Must register with FMCSA and display a USDOT number.
- Comply with safety fitness, driver qualifications, hours of service, and maintenance rules.
- Indirect compensation involving vehicles not otherwise defined as a CMV in section 390.5 in the FMCSRs, according to 390.3(f)(6):
- Must register and display a USDOT number,
- Maintain accident records, and
- Follow driver texting/cell phone restrictions.
Compliance tips
To be certain if your operation is regulated under the FMCSRs or state safety regulations:
- Consult a regulatory expert if your company does not have the expertise;
- Conduct a mock audit (internal or third-party) to identify compliance gaps; and
- Create an action plan, assign responsibilities, and audit compliance regularly.
The FMCSA expects documented efforts to improve safety management controls and compliance.
Key to remember: Businesses must know whether the FMCSRs or state regulations apply to their shuttle operations to minimize negative consequences of noncompliance.
Most Popular Highlights In Human Resources
NewsIndustry NewsIndustry NewsHR GeneralistFamily and Medical Leave Act (FMLA)Family and Medical Leave Act (FMLA)USAHR ManagementEnglishFocus AreaHuman Resources
2023-09-06T05:00:00Z
Appellate court sided with employee's (almost) 3-year-delayed FMLA claim
Back in October 2018, Laffon had a medical emergency and needed some time off under the federal Family and Medical Leave Act (FMLA).
Her leave lasted until November 15. Ten days after she returned to work, on November 26, her employer terminated her.
She sued, arguing that the employer retaliated against her because of her FMLA leave.
The catch? She didn't bring the suit until almost three years later.
No link between leave and termination
In court, the employer argued that there was no causal link between Laffon taking FMLA leave and her termination. Although the court documents aren't robust, they do reveal that the employer indicated that Laffon's allegations didn't show that her taking FMLA leave was a factor in the decision to terminate her. The documents showed only that the termination chronologically followed her leave.
The court agreed with the employer. It also agreed that Laffon failed to allege a willful violation of the FMLA, which would allow her to benefit from the FMLA's three-year statute of limitations.
Laffon appealed the case to the Ninth Circuit.
Statute of limitations
Under the FMLA, employees have two years from the date of the last event constituting the alleged violation for which they can bring a claim.
Those two years are extended to three years if the employer's actions were "willful." This means that an employee must show that the employer either knew or showed reckless disregard for whether its conduct violated the FMLA.
Ruling overturned
Fast forward to August 2023, when the Ninth Circuit reversed the lower court's decision. It indicated that, based on Laffon's amended complaint and liberally construing the law, her allegations establish that her leave was causally connected to her termination and that the employer's action (her termination) was willful.
Glymph v. CT Corporation Systems, No. 22-35735, Ninth Circuit Court of Appeals, August 22, 2023.
Key to remember: Terminating an employee soon after returning from FMLA leave is risky, unless there is a clear, well-documented, non-leave-related reason. Case documents did not show such a clear reason, which can also increase the risk of a willful finding. Employees have time to file claims, even years.
NewsIn-Depth ArticleHR ManagementEnglishHuman ResourcesAssociate Benefits & CompensationIndustry NewsEmployee BenefitsConsumer-driven health plansEmployee BenefitsBenefits communicationHR GeneralistFlexible BenefitsAssociate RelationsFocus AreaUSA
2026-05-28T05:00:00Z
Your employees are lost! Help them better navigate their benefits
There’s a growing gap between the benefits employers offer and the benefits employees use, according to the 2026 Employer Health Benefits Experience survey by the health care navigation platform Castlight Health.
Even though employers are investing in digital health and well-being programs, many workers are skipping employer-sponsored options. Instead, they’re creating their own mix of apps, devices, and online tools, and are often paying for these options themselves.
While most of the 2,000 U.S. employees surveyed have access to multiple benefits, only about one-third understand what’s available to them or even use those benefits.
The survey results indicate that more than half are using at least one consumer health or wellness app, with 46 percent paying with their own money — sometimes hundreds of dollars — for easier tools they find more useful.
This data shows that employees are willing to invest their own money when employer-provided benefits seem too complex or inflexible. It also indicates that employers may not be getting the full return from the benefits they offer.
How employers should respond
- Give employees more benefit flexibility. Employers looking to increase retention should move benefit flexibility to the top of their “to-do” list. When employees have choices, they’re more likely to stay at a company. The survey showed that 80 percent of surveyed employees feel that wellness flexibility would mean they’d be more likely to stay.
- Communicate often about benefits. To encourage employees to make use of company benefits before seeking help on their own, employers must keep benefit messaging in the forefront of employees’ minds. This could be done by sending out regular emails, posting information on the company’s intranet, sending text alerts, etc. Top-of-mind awareness is key!
- Roll with the changes. Employees’ lives are in a constant state of flux, and benefit options need to keep up with that pace to support them no matter what they’re juggling in their personal lives.
- Think beyond open enrollment. The survey revealed that only 7 percent of employees said that the open enrollment period made them think about using their benefits. They’re much more likely to think about what benefits they have when they’re at a doctor’s appointment, or an unexpected need pops up. If employers want their employees to engage with company-sponsored benefits, they should make tools easy to use and available when employees need them the most.
Key to remember: If navigating benefit options is too hard, employees are less likely to make use of their company-sponsored offerings, and might spend their own money on easier-to-use tools.
NewsIndustry NewsIndustry NewsWage and HourWage and HourAssociate Benefits & CompensationAssociate RelationsHR GeneralistFair Labor Standards Act (FLSA)OvertimeHR ManagementEnglishFocus AreaHuman ResourcesUSA
2026-05-21T05:00:00Z
Federal overtime threshold rule gone, for now
On May 15, members of Congress introduced a bill that would gradually increase the overtime salary threshold for determining whether employees may be classified as exempt under the federal Fair Labor Standards Act (FLSA).
This news came on the heels of the U.S. Department of Labor's official rescission of the 2024 rule that increased the threshold. That rule was challenged in federal court, and employers didn’t have to comply with it since it was vacated in November 2024.
Employers may now comfortably continue to follow the 2019 rule, where the minimum salary threshold is $684 per week ($35,568 per year) for executive, administrative, and professional employees, and $107,432 for highly compensated employees.
Potential future increases
The bill, The Restoring Overtime Pay Act of 2026 (HR 8868), would increase the federal minimum salary level as follows:
- 2026 — $45,000
- 2027 — $55,000
- 2028 — $65,000
- 2029 — $75,000
- 2030 — 55th percentile of full-time salaried workers nationally*, updated annually
*The current 55th percentile of full-time salaried workers nationally is $89,440 and could increase to $98,000 by 2030.
The measure would allow the Secretary of Labor to establish a higher salary threshold through notice and comment rulemaking, as long as it can be updated annually.
The bill would also require the following:
- The Secretary of Labor would need to provide annual, automatic updates to the overtime threshold of at least the 55th percentile of weekly earnings of full-time salaried workers.
- If the Secretary doesn’t establish an increased salary threshold, the 55th percentile of weekly earnings of full-time salaried workers nationally would take effect, based on the Bureau of Labor Statistics (BLS) from the second quarter of the preceding calendar year.
- The Secretary would need to publish a notice announcing the revised salary threshold no later than 60 days before the revised threshold takes effect.
- The BLS would need to publicly publish data on its website for each week of each quarter and data on weekly earnings by census region.
The bill is in the first stage of the legislative process. It was referred to the House Committee on Education and Workforce. While it has a small chance of being enacted at this time, it does show that some members of Congress are interested in this topic.
Key to remember: Congress members introduced a bill increasing the federal salary threshold level. But for now, employers can use the 2019 federal salary threshold to determine whether they may classify an employee as exempt.
NewsIndustry NewsAssociate Benefits & CompensationHR GeneralistFamily and Medical Leave Act (FMLA)In-Depth ArticleFamily and Medical Leave Act (FMLA)Associate RelationsEnglishHR ManagementFocus AreaHuman ResourcesUSA
2025-03-27T05:00:00Z
Who can fill out FMLA forms? The answer might surprise you
One of the most common questions involving the federal Family and Medical Leave Act (FMLA) that we see is: “Can ________ fill out the medical certification?”
This question stumps a lot of HR people and can be a little confusing.
It might be easier to start with who CAN’T fill out an FMLA certification. That includes your coworker, best friend, neighbor, or pet.
Jokes aside, often (but not always) a doctor fills out the FMLA certification, and since March 30 is “Doctors’ Day,” this is a great time to discuss this topic.
FMLA certification basics
Employers aren’t required to use certifications, but if they do, the U.S. Department of Labor (DOL) has five different certification forms to use for various FMLA leave situations.
The forms are as follows:
- Certification of Health Care Provider for Employee's Serious Health Condition,
- Certification of Health Care Provider for Family Member's Serious Health Condition,
- Certification of Qualifying Exigency for Military Family Leave,
- Certification for Serious Injury or Illness of a Current Servicemember for Military Family Leave, and
- Certification for Serious Injury or Illness of a Veteran for Military Family Leave.
Let’s focus on the first two, as these are the most common ones HR administrators use.
Who can fill out an FMLA certification?
The FMLA regulations describe the person who has the authority to fill out a certification as a “health care provider.” The good news is, the regulations include a lengthy list of medical professionals who fit this role.
Under the FMLA, a health care provider includes:
- A doctor of medicine or osteopathy,
- A podiatrist,
- A dentist,
- A clinical psychologist,
- An optometrist,
- A chiropractor (limited to manual manipulation of the spine as demonstrated by X-ray),
- A nurse practitioner,
- A nurse midwife,
- A clinical social worker,
- A physician assistant,
- A Christian Science practitioner, and
- Any health care provider from whom the employer or the employer's group health plan's benefits manager will accept a medical certification to substantiate a claim for benefits.
To be qualified to fill out FMLA forms, medical professionals must be authorized to practice in the state and perform within the scope of their practice. This means that the provider must be authorized to diagnose and treat physical or mental health conditions.
What about doctors in a foreign country?
If an employee or an employee's family member is visiting another country, or a family member resides in another country, and a serious health condition develops, the employer must accept a medical certification from a health care provider who practices in that country. This includes second and third opinions.
If a medical certification from a foreign health care provider is not in English, the employee may be required to provide a written translation of the certification.
Key to remember: The FMLA regulations spell out which medical professionals can fill out certification forms.
NewsIndustry NewsIn-Depth ArticleFamily and Medical Leave Act (FMLA)Family and Medical Leave Act (FMLA)USAHR ManagementEnglishFocus AreaHuman Resources
2023-07-20T05:00:00Z
Dealing with FMLA Monday/Friday absences
The federal Family and Medical Leave Act (FMLA) allows eligible employees to take job-protected leave for certain qualifying reasons. Over the years, employees have gotten creative when scheduling such leave, including taking it on Mondays and/or Fridays to extend a weekend.
Employers trying to oversee schedules and meet other business needs might get frustrated when employees take leave. When employees take leave in suspicious patterns, the frustration swells.
It doesn’t help that the FMLA restricts when and how employers may obtain information on the reasons behind leave.
Employers, however, do have some resources available to them when determining whether a Monday/Friday absence pattern is valid, or if the employee is abusing leave.
Recertifying FMLA leave
Once employers have a certification supporting the need for a leave, they may not request recertification more often than every 30 days, or until the minimum duration of the condition listed on the certification has expired.
Employers may, however, request recertification more often if:
- The employee requests an extension of leave,
- Circumstances described by the initial certification have changed significantly, or
- They receive information that casts doubt upon the reason for leave or the continuing validity of the certification.
When employers suspect FMLA abuse, they should review the information contained in the certification to see if the absences match. If not, they may investigate the situation further.
Asking about absence patterns
To help with this investigation, when requesting a recertification, employers may include a record of the employee’s absences and ask the health care provider if the pattern is consistent with the serious health condition.
It’s true that employers may not generally contact the employee’s health care provider directly for this information, but they may add this type of question to the medical recertification form, and direct the employee to have it completed.
Tracking absences
In such situations, employers might want to review the absence patterns of employees in question and be on the lookout for suspicious absences in the future.
Effectively tracking all leave is a must to identify patterns that could indicate FMLA leave abuse. If employers learn that an absence is not for a valid FMLA-qualifying reason, the employee is not entitled to the protections of the law for such an absence.
Key to remember: If employees are suspiciously taking FMLA leave such as on Mondays and Fridays, employers may request a recertification supporting the leave pattern.
NewsIndustry NewsNational Labor Relations Act (NLRA)National Labor Relations Board (NLRB)Privacy and Data SecurityUnions/Labor RelationsHR GeneralistFocus AreaIn-Depth ArticlePrivacy and Data SecurityEnglishHR ManagementAssociate RelationsHuman ResourcesUSA
2024-04-15T05:00:00Z
Does ‘Don’t cover your dash cam’ violate employee rights?
The U.S. Court of Appeals for the D.C. Circuit ruled in late March that a produce company did not violate federal labor law by telling a pro-union truck driver not to cover up a surveillance camera in the cab of his truck.
The unanimous three-judge panel said that because the company had a policy requiring drivers to keep the cameras on "at all times," it did not infringe on the driver's rights when the driver, who parked for a lunch break and covered the truck’s inward facing camera, received a text from a supervisor saying, “you can’t cover the camera it’s against company rules.”
The National Labor Relations Board (NLRB) had claimed that the employer violated the National Labor Relations Act (NLRA) with that text.
"The Board’s explanation is nonsense," Circuit Judge A. Raymond Randolph wrote. "There is nothing ambiguous about 'at all times.'"
The NLRB had said that the supervisor’s text illegally created the impression that the driver was being watched because of the driver’s support for a union organizing campaign and involvement in another NLRB case against the company.
An NLRB law makes it illegal for an employer to create an “impression of surveillance” that discourages employees from discussing or engaging in union activities.
But the D.C. Circuit said the driver was aware of the company's constant surveillance of truck cabs for safety reasons and that it was unlikely he would engage in organizing while on the job.
Strong policies are a best practice
The judges in this case used the employer’s policies to determine that it had not violated the NLRA. What employers should take away from this case, therefore, is that if they use video cameras to observe employees — whether employees are working in the office, remotely from home, or in a vehicle — they should develop and communicate clear polices regarding the expectation of privacy on the job.
In addition, employers should train supervisors on the enforcement of such policies. This is especially important when it comes to employee rights to organize.
In this case, for example, stronger actions by the supervisor directed at a driver who was involved in organizing efforts, could have created an impression of surveillance coercing the employee in the exercise of his rights. Manager training may be useful in avoiding and/or defending against such claims, as well as other claims relating to discrimination, invasion of privacy, harassment, etc.
Similar cases on the horizon?
Other cases like this might be forthcoming, since in October 2022, the NLRB's general counsel issued a memo stating concern about employers increasingly using monitoring systems like cameras. The memo noted plans to “urge the Board, to the greatest extent possible, to apply the Act to protect employees from intrusive or abusive electronic monitoring and automated management practices that would have a tendency to interfere with Section 7 rights.” In response to the memo, the NLRB adopted the position that an employer's use of technology to monitor productivity can violate the National Labor Relations Act (NLRA), whether or not the technology was being used specifically to monitor union activity.
Key to remember: A federal appeals court ruled that a supervisor’s reminder to an employee that covering a driver-facing dash cam was against company policy was not a violation of the NLRA. This case should serve as a reminder to employers that clear communication, strong policies, and supervisor training must accompany any employee surveillance.
Stern Produce Company, Inc. v. NLRB, No. 23-1100 (D.C. Cir. 2024)
Most Popular Highlights In Safety & Health
NewsIndustry NewsMaterials Handling and StorageSafety & HealthConstruction SafetyGeneral Industry SafetyMaterials Handling and StorageIn-Depth ArticleEnglishFocus AreaUSA
2026-05-28T05:00:00Z
Material handling, when handling without care
Powered industrial truck regulations consistently rank among OSHA’s most cited. Many of these events don’t involve unusual conditions. They happen during routine work, in spaces employees navigate every day.
Injury and enforcement trends repeatedly point to struck by and caught between hazards that develop during normal operations. These are not rare events. They are recurring outcomes tied to how material is moved, stored, and managed.
Movement multiplies risk
Material handling means motion, equipment in travel lanes, loads shifting as they move, and workers crossing forklift paths. Every movement adds exposure, and it can escalate fast when tasks overlap or the area gets congested.
Moving pallets, operating forklifts, stacking materials, and stocking shelves are normal tasks, but each one can affect movement, storage, and load stability. OSHA data and enforcement trends continue to show serious injuries and fatalities tied to these types of activities. Material handling risks are more likely when:
- Forklifts and pedestrians share the same travel paths;
- Loads are lifted, carried, or stacked beyond stable limits;
- Visibility is reduced due to product, layout, or speed;
- Aisles become obstructed or narrowed during operations; or
- Tasks overlap without clear coordination of movement.
Stack safe, store smart
Safe storage practices reduce the chance that routine handling turns into a collapse, spill, or struck-by event. A slightly uneven stack, an overloaded pallet, or a rack pushed beyond capacity can fail quickly under normal workplace conditions. Strong storage practices can greatly reduce risk by:
- Maintaining pallet loads that are even, stable, and securely stacked;
- Verifying stacks stay within rack and pallet ratings;
- Keeping materials within designated storage boundaries; and
- Removing damaged pallets or containers from service.
Control, not complacency
Serious incidents are often less about equipment failure and more about familiar work being performed without enough attention to current conditions. Operators rely on experience instead of staying alert to the situation in front of them, pedestrians assume they have been seen, and routine tasks continue even when aisles tighten, loads change, or travel paths become less controlled.
Exposure to risks quickly rise when assumptions replace attention and routine replace active hazard recognition. Real control means staying actively engaged, maintaining awareness, checking conditions, verifying paths, and recognizing when conditions change.
Expect inspections
For both managers and workers, consistent inspections are one of the best ways to catch changing conditions before they lead to injury. Strong inspection practices can include:
- Checking travel paths and pedestrian separation throughout the shift;
- Removing damaged pallets, racks, or equipment from service;
- Identifying congestion points before they disrupt workflow; and
- Reinforcing that inspections support safe operations.
Training smart, work safe
Training for material handling is often centered on equipment operation. However, effective training focuses on recognizing changing conditions, understanding interaction between people and equipment, and reinforcing when to stop, reassess, and adjust.
To minimize the risks from constant movement in material handling environments, employers should implement clear traffic management strategies, such as designated pedestrian walkways and marked forklift lanes. Strong training reinforces decisions such as:
- Identifying when pedestrian separation is no longer maintained,
- Recognizing unstable loads before movement begins,
- Understanding when speed or congestion increases exposure,
- Stopping work when conditions no longer support safe handling, or
- Recognizing when a different method is the safer option.
Key to remember: When loads stay stable, travel paths stay clear, and workers stay alert to changing conditions, routine material handling activities stay productive, controlled, and far less likely to become a serious incident.
NewsIndustry NewsEnglishSafety & HealthConstruction SafetyGeneral Industry SafetyIn-Depth ArticleHazard CommunicationHazard CommunicationHazcom LabelingUSAFocus AreaHazCom Written ProgramHazCom Information and Training
2026-05-28T05:00:00Z
November's HazCom GHS 7 Deadline: What employers need to know
OSHA’s updated Hazard Communication Standard, now aligned with the 7th revised edition of the Globally Harmonized System of Classification and Labeling of Chemicals (GHS 7), is being rolled out in phases. One deadline passed in May, and the next arrives in November. For employers, this means now is the time to start making updates. This revision introduces enough meaningful changes that relying on an old hazard communication checklist will not be enough.
First, a Quick Refresher on What HazCom Actually Is
At its core, OSHA’s Hazard Communication Standard is designed to make sure workers know what chemicals they are working with and what hazards those chemicals present. It covers the labels on chemical containers, the Safety Data Sheets (SDSs) that provide detailed hazard information, and the training employees need so they can understand and use that information effectively.
HazCom is tied to the Globally Harmonized System, or GHS, an international framework developed by the United Nations to create a more consistent approach to classifying and communicating chemical hazards. When the UN updates the GHS, OSHA eventually updates HazCom to better align with it. That is what is happening now with GHS 7, and those updates are beginning to work their way into supplier documents and workplace compliance expectations.
What’s Actually Changing in GHS 7
So what is different this time? GHS 7 includes several substantive changes that affect how chemicals are classified, how SDSs are written, and how labels are presented. These are not just wording updates. In some cases, they can change how hazards are described and how information is communicated to workers. The changes are:
- New and Revised Hazard Categories: GHS 7 expands classification for certain health and physical hazards. Desensitized explosives, for example, now have their own hazard class. Some existing categories have been refined with new subcategories that require different labeling and SDS language.
- Updated SDS Requirements: Section formatting and content requirements are being revised in several areas. Employers and chemical manufacturers will need to review existing SDS documents to ensure they reflect the updated classification criteria and language. If you’re an employer who receives SDS from suppliers, you’ll need to verify that incoming documents meet the new standard.
- Label Changes: Some products will require updated pictograms, signal words, or hazard statements based on reclassification under GHS 7. That means physical labels on containers may need to be reprinted and replaced.
- Exposure Limits and Inhalation Hazards: GHS 7 brings more specificity to how inhalation hazards are communicated, particularly for aerosols and mixtures.
What the May Deadline Covered
OSHA’s GHS 7 update was not designed as a single cutoff date. Instead, it was rolled out in phases, with different obligations applying at different points in time. The May 2026 deadline primarily affected chemical manufacturers, importers, and distributors. By then, those upstream parties were expected to update chemical classifications and begin issuing labels and SDSs that align with the revised standard.
For employers, that phase matters because it marks the point when updated information should begin flowing into the workplace. If you receive hazardous chemicals from suppliers, the SDSs and shipped labels you get should increasingly reflect the new classification language and formatting requirements.
That does not mean employers can treat compliance as only a supplier issue. You are still responsible for making sure the SDSs in your workplace are current, your labels reflect the hazards of the chemicals in use, and employees are trained on the information they rely on. If a supplier is slow to update documentation, that gap can quickly become your problem during an inspection.
That is why now is the time to start reaching out to chemical vendors and reviewing your own program. Ask suppliers whether their SDSs have been updated to GHS 7 standards, track what you receive, and follow up on anything that is missing or unclear. November will arrive quickly, and employers that wait too long may find themselves rushing through updates that should have been planned in advance.
Roadmap for November Update
The best way to approach the November deadline is as a practical compliance project rather than a last-minute document review.
- Chemical inventory audit: You cannot update what you have not identified, so pull together a complete inventory of every chemical in the workplace, including cleaning products, maintenance supplies, and production materials. That inventory becomes the baseline for everything that follows.
- Review and update your SDS library: Contact suppliers and request GHS 7-compliant SDSs for each product on your inventory. Do not assume existing files are already current. Create a simple tracking system so you know which documents have been updated, which are still pending, and where follow-up is needed.
- Audit your physical labels: Walk the facility and compare container labels to the updated hazard information you are receiving. If products have been reclassified or now use different pictograms, signal words, or hazard statements, your in-house labels may also need to change. Starting early is important, especially for larger facilities where relabeling can take time.
- Revise your written HazCom program: This should be treated as a living document that reflects current practice. Review it carefully and update language, procedures, and responsibilities so they align with the revised standard and with the way your facility actually manages chemical hazards.
- Retrain your workforce and brief supervisors: Employees need to understand what changed, what updated labels and SDSs mean, and how those changes affect handling, storage, and response expectations. Supervisors should receive deeper guidance so they can answer questions, recognize compliance gaps, and reinforce the updated program in day-to-day operations.
Key to remember: Now is the time to prepare for November's Hazard Communication Standard deadline.
NewsIndustry NewsSafety & HealthGeneral Industry SafetyExpert InsightsFire Protection and PreventionEnglishFire Protection and PreventionFocus AreaUSA
2026-05-29T05:00:00Z
Expert Insights: Safety often born of tragedy
The more I understand OSHA’s regulations and answer questions from safety professionals, the more I keep an eye out for safety wherever I go, whether it’s being alert to where the exits are or whether workers are using personal protective equipment while on a roof in my neighborhood.
Working in the safety field also has meant becoming familiar with tragic events like the 1911 Triangle Shirtwaist Factory Fire, in which 146 workers died. More recently, during a walk along Boston’s historic Freedom Trail and surrounding areas, I discovered the Boston Fire Museum and a tragedy I hadn’t heard of.
While exploring the fire trucks and memorabilia, a wall display caught my eye. Intrigued by a newspaper headline — “400 Dead in Hub Night Club Fire” — I read on and learned something new.
Just after Thanksgiving in 1942, nearly 500 people died when a fire broke out in the basement bar of the Cocoanut Grove supper club. It’s believed the fire ignited when a busboy lit a match to better see while fixing a lightbulb near an artificial palm tree.
Within minutes, decorations and furnishings caught fire, sending a fireball of flame and toxic gases racing toward the only exit — a four-foot-wide staircase leading to the first floor, which housed restrooms, coatrooms, and the main entrance. As people tried to escape, the revolving door jammed with panicked patrons.
Later, investigators determined that several alternative exits had been blocked or locked, the building was overcrowded, and flammable building materials and highly combustible decorations contributed to the rapid spread of the fire. A lack of sprinklers and smoke detectors also increased the scale of devastation.
The fire triggered significant reforms that continue to drive compliance, including:
- Exit design and egress requirements,
- Exit visibility and emergency lighting,
- Control of flammable materials such as interior decorations,
- Occupancy limits and enforcement,
- Fire protection systems, and
- Creation of fire safety oversight and codes.
Many safety laws and regulations exist today because of real tragedies, some predating OSHA by decades. The Cocoanut Grove fire is just one example.
NewsIndustry NewsSafety & HealthConstruction SafetyInjury and Illness Recording CriteriaGeneral Industry SafetyIn-Depth ArticleUSAEnglishFocus AreaInjury and Illness Recordkeeping
2023-10-18T05:00:00Z
Can I get a second opinion? I want to delete an OSHA recordable
Getting a second opinion regarding an injured employee’s need for medical treatment, restrictions, or days away might allow an employer to avoid recording the incident on the 300 Log, but OSHA does impose some limitations.
Normally, a mere recommendation for medical treatment, restrictions, or days away makes a case recordable, even if the employee does not to follow that recommendation. However, OSHA allows employers to avoid recording an incident based on a “contemporaneous” second opinion that is more “authoritative.” If the employee receives medical treatment, however, a second opinion cannot negate the obligation to record the case.
Contemporaneous defined
OSHA does not define “contemporaneous” in the regulations, but offered clarification in a letter of interpretation (LOI) dated May 15, 2007. The evaluations must be conducted when the signs or symptoms are in the same stage of development, same degree of severity, and the condition is evaluated in similar context.
Opinions obtained on the same day would be contemporaneous. Acceptable time delays may differ depending on circumstances, including the type and severity of the condition. For instance, if the employee’s condition either improved or worsened between examinations, the condition would not be evaluated at the same stage.
An employer presented a scenario in an LOI dated September 24, 2010. An employee fell from a chair, went to the emergency room, and was given restrictions that did not affect his duties. Ten days later, the employee visited an occupational clinic and was released to full duty. Finally, after another four days (14 days after the initial ER visit), the employee visited a chiropractor who recommended days away. The employer wanted to consider the initial opinions as more “authoritative” to avoid recording days away. However, OSHA noted that the opinions were not contemporaneous so the question of authority was moot. The employer had to record the case. The employee’s injury might have worsened due to activities outside work, but since the condition started at work, OSHA considers it work-related.
In another LOI dated February 25, 2011, OSHA offered additional considerations regarding “contemporaneous” opinions to include:
- Whether the examination was in person (reviewing documents is not sufficient);
- Whether the examinations were done on the same day;
- Whether the employee was subjected to additional events or exposures between the examinations; and
- Whether medical treatment, restricted work activity, or days away occurred between the examinations.
Authoritative defined
The regulation at 1904.6(b)(3) defines “authoritative” as the “best documented, best reasoned, or most authoritative.” The 2010 LOI mentioned previously clarifies that the most authoritative opinion is “the best documented, the best reasoned, or the most persuasive.”
OSHA allows employers to make that determination. In fact, the preamble published in 2001 says, “the rule requires the employer to rely on the one judged by the employer to be most authoritative.” Also, a frequently asked question in OSHA’s Recordkeeping Policies and Procedures Manual (CPL 02-00-135) states, “the employer may determine which recommendation is the most authoritative and record on that basis.”
So, if an injured employee gets a recommendation for medical treatment, restrictions, or days away, but the employer obtains a contemporaneous opinion contradicting that recommendation and the second opinion is more authoritative, the employer may follow the second opinion. However, once medical treatment is provided, the employer must record the case. A subsequent recommendation cannot “undo” a recommendation that was already followed or implemented.
Key to remember: Employers can record cases based on second opinions if the evaluation was both contemporaneous and more authoritative.
NewsIndustry NewsIndustry NewsEnforcement and Audits - OSHASafety & HealthConstruction SafetyGeneral Industry SafetyAgriculture SafetyMaritime SafetyFocus AreaEnglishOSHA Violations and PenaltiesUSA
2026-05-28T05:00:00Z
OSHA penalty amounts won’t increase in 2026
OSHA won’t increase its penalty amounts in 2026. The agency is required to annually adjust its penalties for inflation, based specifically on the October Consumer Price Index for All Urban Consumers (CPI-U) data released by the Bureau of Labor Statistics (BLS). Due to a lapse in funding, BLS did not release the October 2025 data. Because no alternative calculation is allowed, OSHA penalties will remain at the 2025 amounts.
| Type of violation | Penalty |
| Serious Other-than-serious Posting requirements | $16,550 per violation |
| Failure to abate | $16,550 per day beyond the abatement date |
| Willful or repeated | $165,514 per violation |
NewsEmergency Planning - OSHAIndustry NewsSafety & HealthElectrical SafetyGeneral Industry SafetyEmergency ExitsFire Protection and PreventionIn-Depth ArticleFire ExtinguishersEnglishClearance DistancesFocus AreaUSA
2022-07-08T05:00:00Z
Locked/blocked exits prompt $580K in OSHA penalties
A national retailer, with what OSHA calls a long history of violations, was slapped with four willful citations after local fire officials sent a referral to the agency regarding a Wisconsin store. Once inside the store last December and January, OSHA inspectors found a:
- Locked exit — Emergency exit doors to the back receiving room were padlocked with a bike lock and a board placed through the handles. Employees were not able to open an exit route door from the inside at all times without keys, tools, or special knowledge. This violated 29 CFR 1910.36(d)(1). The violation was considered willful and serious because the retailer had previously been cited for the same violation three times elsewhere in the U.S. Now the store received the maximum penalty of $145,027.
- Blocked exit — Merchandise and carts blocked the exit in the receiving room, according to OSHA. The exit route was not kept free and unobstructed, and violated 1910.37(a)(3). This violation too was considered willful and serious because the retailer had been cited previously for the same violation 12 times in the U.S. This time the penalty was the maximum $145,027.
- Blocked extinguisher — A portable fire extinguisher in the back receiving room was obstructed with carts/containers. The extinguishers were not readily accessible per 1910.157(c)(1). OSHA found that the retailer previously violated this regulation twice in the U.S., so the violation was considered willful and serious and picked up another maximum $145,027 penalty.
- Blocked electrical panel — Adequate space around electrical panels was not provided says OSHA. Inspectors found that the employer obstructed the access and working space about electrical panels with carts/containers, in violation of 1910.303(g)(1). The citation explains that the retailer violated that regulation eight previous times in the U.S., and the violation was willful and serious, but OSHA did not propose a penalty amount.
While store managers explained that the doors needed repair to close properly, OSHA determined the doors were in disrepair for three months. The store has settled the case for $435,081 in penalties.
However, in January, a similar inspection was conducted at another one of the retailer’s stores in Ohio. That location was cited for barrel locks on the inside of a double-door emergency exit in the back room in violation of 1910.36(d)(1) . The Ohio store was cited for one willful violation and settled the case with $145,027 in penalties.
It is noteworthy that officials for the company had signed settlement agreements with OSHA in 2017, promising to resolve similar violations at its stores nationwide. However, OSHA officials say, based on the latest violations, the retailer continues to gamble with workers’ lives and must stop before tragedy strikes.
Saved to my EVENT CALENDAR!
View your saved links by clicking the arrow next to your profile picture located in the header. Then, click “My Activity” to view the Event Calendar on your Activity page.
OK
J. J. Keller is the trusted source for DOT / Transportation, OSHA / Workplace Safety, Human Resources, Construction Safety and Hazmat / Hazardous Materials regulation compliance products and services. J. J. Keller helps you increase safety awareness, reduce risk, follow best practices, improve safety training, and stay current with changing regulations.
Copyright 2026 J. J. Keller & Associate, Inc. For re-use options please contact copyright@jjkeller.com or call 800-558-5011.




















































